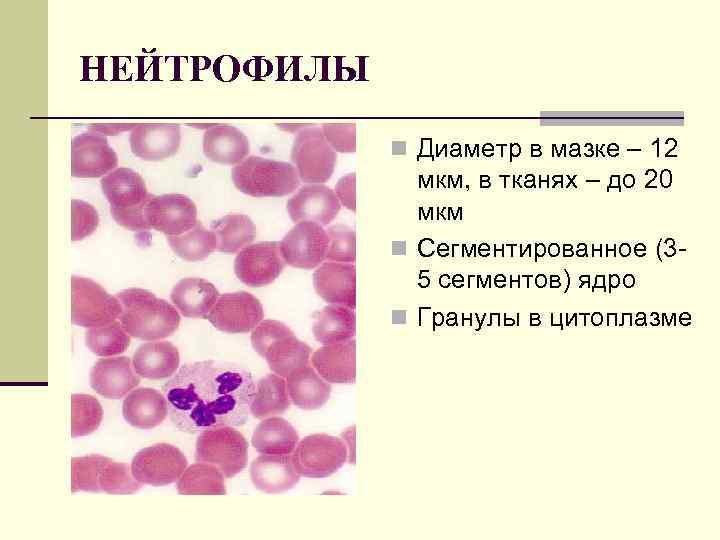
НЕЙТРОФИЛЫ n Диаметр в мазке – 12 мкм, в тканях – до 20 мкм

Lektsia_6krov.ppt1685496124.ppt
- Количество слайдов: 122
 КРОВЬ и ЛИМФА Межклеточное вещество КЛЕТОЧНЫЙ СОСТАВ КРОВИ (ФОРМЕННЫЕ ЭЛЕМЕНТЫ КРОВИ) И ЕГО ФИЗИОЛОГИЧЕСКАЯ ЛАБИЛЬНОСТЬ ЦИТОЛОГИЧЕСКИЕ ОСОБЕННОСТИ ФОРМЕННЫХ ЭЛЕМЕНТОВ КРОВИ ФУНКЦИИ ФОРМЕННЫХ ЭЛЕМЕНТОВ КРОВИ
КРОВЬ и ЛИМФА Межклеточное вещество КЛЕТОЧНЫЙ СОСТАВ КРОВИ (ФОРМЕННЫЕ ЭЛЕМЕНТЫ КРОВИ) И ЕГО ФИЗИОЛОГИЧЕСКАЯ ЛАБИЛЬНОСТЬ ЦИТОЛОГИЧЕСКИЕ ОСОБЕННОСТИ ФОРМЕННЫХ ЭЛЕМЕНТОВ КРОВИ ФУНКЦИИ ФОРМЕННЫХ ЭЛЕМЕНТОВ КРОВИ
 ОСОБЕННОСТИ КРОВИ КАК ТКАНИ МЕЗЕНХИМАЛЬНОЕ ПРОИСХОЖДЕНИЕ ЖИДКАЯ КОНСИСТЕНЦИЯ ШИРОКИЙ СПЕКТР ФУНКЦИЙ УНИКАЛЬНОСТЬ ЦИТОЛОГИЧЕСКИХ ОСОБЕННОСТЕЙ КЛЕТОЧНЫХ КОМПОНЕНТОВ n ВЫСОКАЯ ФИЗИОЛОГИЧЕСКИ ЗНАЧИМАЯ ЛАБИЛЬНОСТЬ СОСТАВА n n
ОСОБЕННОСТИ КРОВИ КАК ТКАНИ МЕЗЕНХИМАЛЬНОЕ ПРОИСХОЖДЕНИЕ ЖИДКАЯ КОНСИСТЕНЦИЯ ШИРОКИЙ СПЕКТР ФУНКЦИЙ УНИКАЛЬНОСТЬ ЦИТОЛОГИЧЕСКИХ ОСОБЕННОСТЕЙ КЛЕТОЧНЫХ КОМПОНЕНТОВ n ВЫСОКАЯ ФИЗИОЛОГИЧЕСКИ ЗНАЧИМАЯ ЛАБИЛЬНОСТЬ СОСТАВА n n
 КРОВЬ (SANGUIS, HAIMA) Общий объем крови составляет в среднем около 7% от веса тела (около 5 л у взрослого). Состоит из плазмы - своеобразное по происхождению и функциям межклеточное вещество 55 60 % объёма крови и взвешенных в ней форменных элементов 40 45 % объёма крови.
КРОВЬ (SANGUIS, HAIMA) Общий объем крови составляет в среднем около 7% от веса тела (около 5 л у взрослого). Состоит из плазмы - своеобразное по происхождению и функциям межклеточное вещество 55 60 % объёма крови и взвешенных в ней форменных элементов 40 45 % объёма крови.
 ОБЪЁМНОЕ СООТНОШЕНИЕ ФОРМЕННЫХ ЭЛЕМЕНТОВ И ПЛАЗМЫ КРОВИ ДОЛЯ ОБЪЁМА, ПРИХОДЯЩАЯСЯ НА ФОРМЕННЫЕ ЭЛЕМЕНТЫ, НАЗЫВАЕТСЯ ГЕМАТОКРИТОМ. ГЕМАТОКРИТ НОРМАЛЬНОЙ КРОВИ: n у мужчин – 44 49% n у женщин – 41 46%
ОБЪЁМНОЕ СООТНОШЕНИЕ ФОРМЕННЫХ ЭЛЕМЕНТОВ И ПЛАЗМЫ КРОВИ ДОЛЯ ОБЪЁМА, ПРИХОДЯЩАЯСЯ НА ФОРМЕННЫЕ ЭЛЕМЕНТЫ, НАЗЫВАЕТСЯ ГЕМАТОКРИТОМ. ГЕМАТОКРИТ НОРМАЛЬНОЙ КРОВИ: n у мужчин – 44 49% n у женщин – 41 46%
 функции крови: n 1. Трофические (доставка к тканям питательных веществ). 2. Защитная (фагоцитоз, иммунная защита). 3. Газообмен, т. е. дыхательная функция. 4. Гомеостатическая функция. 5. Интегративная функция (участвует в гуморальной регуляции, транспортируя гормоны и биологически активные вещества). 6. Гемокоагуляционная
функции крови: n 1. Трофические (доставка к тканям питательных веществ). 2. Защитная (фагоцитоз, иммунная защита). 3. Газообмен, т. е. дыхательная функция. 4. Гомеостатическая функция. 5. Интегративная функция (участвует в гуморальной регуляции, транспортируя гормоны и биологически активные вещества). 6. Гемокоагуляционная
 Плазма n Жидкая часть крови желтоватого цвета, в состав входят n n различные соли (электролиты), белки, и растворенные в ней газы Плазма состоит на 90% из воды, 9% из органических (6% из них белки альбумины, глобулины, фибриноген и протромбин), липиды ( линоевая кислота , холестерин , лизофосфатидная кислота , простагландины ); углеводы, ферменты, витамины полипептидные факторы роста (инсулин , инсулиноподобные факторы роста I и II); непептидные гормоны ( кортизол , гидрокортизон), эстрогены , андрогены , тиреоидные гормоны (T 3 , T 4 ); метаболиты ( аминокислоты , альфа кетокислоты (пируват ), полиамины ); 1% из неорганических веществ в свободном состоянии или в связи со специальными транспортными белками. ( Fe 2+ , Zn 2+ , Cu 2+ , Mn 2+ , Se. O 3 2+ , Co 2+ , VO 3 , Mo )
Плазма n Жидкая часть крови желтоватого цвета, в состав входят n n различные соли (электролиты), белки, и растворенные в ней газы Плазма состоит на 90% из воды, 9% из органических (6% из них белки альбумины, глобулины, фибриноген и протромбин), липиды ( линоевая кислота , холестерин , лизофосфатидная кислота , простагландины ); углеводы, ферменты, витамины полипептидные факторы роста (инсулин , инсулиноподобные факторы роста I и II); непептидные гормоны ( кортизол , гидрокортизон), эстрогены , андрогены , тиреоидные гормоны (T 3 , T 4 ); метаболиты ( аминокислоты , альфа кетокислоты (пируват ), полиамины ); 1% из неорганических веществ в свободном состоянии или в связи со специальными транспортными белками. ( Fe 2+ , Zn 2+ , Cu 2+ , Mn 2+ , Se. O 3 2+ , Co 2+ , VO 3 , Mo )
 n В норме р. Н крови соответствует 7, 36, т. е. реакция слабоосновная. Колебания величины р. Н крови крайне незначительны. n При различных физиологических состояниях р. Н крови может изменяться как в кислую (до 7, 3), так и в щелочную (до 7, 5) сторону. n при р. Н крови 6, 95 наступает потеря сознания, и смерть. n Если же концентрация ионов Н+ уменьшается и р. Н становится равным 7, 7, то наступают тяжелейшие судороги (тетания)
n В норме р. Н крови соответствует 7, 36, т. е. реакция слабоосновная. Колебания величины р. Н крови крайне незначительны. n При различных физиологических состояниях р. Н крови может изменяться как в кислую (до 7, 3), так и в щелочную (до 7, 5) сторону. n при р. Н крови 6, 95 наступает потеря сознания, и смерть. n Если же концентрация ионов Н+ уменьшается и р. Н становится равным 7, 7, то наступают тяжелейшие судороги (тетания)
 Состав плазмы отличается лишь относительным постоянством и во многом зависит от приема пищи, воды и солей. В то же время концентрация глюкозы, белков, всех катионов, хлора и гидрокарбонатов удерживается в плазме на довольно постоянном уровне и лишь на короткое время может выходить за пределы нормы. Значительные отклонения этих показателей от средних величин на длительное время приводят к тяжелейшим последствиям для организма, зачастую несовместимым с жизнью. Содержание же других составных элементов плазмы — фосфатов, мочевины, мочевой кислоты, нейтрального жира может варьировать в довольно широких пределах, не вызывая расстройств функции организма.
Состав плазмы отличается лишь относительным постоянством и во многом зависит от приема пищи, воды и солей. В то же время концентрация глюкозы, белков, всех катионов, хлора и гидрокарбонатов удерживается в плазме на довольно постоянном уровне и лишь на короткое время может выходить за пределы нормы. Значительные отклонения этих показателей от средних величин на длительное время приводят к тяжелейшим последствиям для организма, зачастую несовместимым с жизнью. Содержание же других составных элементов плазмы — фосфатов, мочевины, мочевой кислоты, нейтрального жира может варьировать в довольно широких пределах, не вызывая расстройств функции организма.
 Белки плазмы n Используя метод высаливания нейтральными солями, белки плазмы крови можно разделить на три группы: альбумины, глобулины и фибриноген. Плазма крови, лишенная фибриногена, называется сывороткой. n Синтез белков плазмы крови осуществляется преимущественно в клетках печени и ретикулоэндотелиальной системы.
Белки плазмы n Используя метод высаливания нейтральными солями, белки плазмы крови можно разделить на три группы: альбумины, глобулины и фибриноген. Плазма крови, лишенная фибриногена, называется сывороткой. n Синтез белков плазмы крови осуществляется преимущественно в клетках печени и ретикулоэндотелиальной системы.
 Белки плазмы n Транспортные альбумины 54 58%, (молекулярная масса около 70 000). n транспортирует свободные жирные кислоты, билирубин, Са 2+, Сu 2+, триптофан, тироксин и трийодтиронин. Многие лекарства (аспирин, сульфаниламиды) связываются в крови с альбумином. Трансферрин (транспорт ионов железа), гаптоглобин (связывание гемоглобина), церулоплазмин (транспорт ионов меди)
Белки плазмы n Транспортные альбумины 54 58%, (молекулярная масса около 70 000). n транспортирует свободные жирные кислоты, билирубин, Са 2+, Сu 2+, триптофан, тироксин и трийодтиронин. Многие лекарства (аспирин, сульфаниламиды) связываются в крови с альбумином. Трансферрин (транспорт ионов железа), гаптоглобин (связывание гемоглобина), церулоплазмин (транспорт ионов меди)
 n Белки, участвующие в иммунных реакциях n Иммуноглобулины Ig (Ig. G, Ig. E, Ig. А, Ig. М, Ig. D) n α 1 глобулины 6 7%, α 2 глобулины 8 9%, β глобулины 13 14%, γ глобулины 11 12% (молекулярная масса до 450 000) n Белки комплемента (С 1 С 9)– инициируют реакции воспаления
n Белки, участвующие в иммунных реакциях n Иммуноглобулины Ig (Ig. G, Ig. E, Ig. А, Ig. М, Ig. D) n α 1 глобулины 6 7%, α 2 глобулины 8 9%, β глобулины 13 14%, γ глобулины 11 12% (молекулярная масса до 450 000) n Белки комплемента (С 1 С 9)– инициируют реакции воспаления
 Белки системы свертывания крови n Коагулянты – тромбопластин, фибриноген n и антикоагулянты – компоненты фибринолитической системы (антитромбин III , кофактор II гепарина , протеин C и протеин S).
Белки системы свертывания крови n Коагулянты – тромбопластин, фибриноген n и антикоагулянты – компоненты фибринолитической системы (антитромбин III , кофактор II гепарина , протеин C и протеин S).
 Функции белков плазмы крови Ø белки обеспечивают онкотическое давление Ø Ø крови, от которого в значительной степени зависит обмен воды и растворенных в ней веществ между кровью и тканевой жидкостью (белки, являясь коллоидами, связывают воду и задерживают ее, не позволяя выходить из кровяного русла); регулируют р. Н крови благодаря наличию буферных свойств; влияют на вязкость крови и плазмы, что чрезвычайно важно для поддержания нормального уровня кровяного давления, обеспечивают гуморальный иммунитет, ибо являются антителами (иммуноглобулинами); принимают участие в свертывании крови;
Функции белков плазмы крови Ø белки обеспечивают онкотическое давление Ø Ø крови, от которого в значительной степени зависит обмен воды и растворенных в ней веществ между кровью и тканевой жидкостью (белки, являясь коллоидами, связывают воду и задерживают ее, не позволяя выходить из кровяного русла); регулируют р. Н крови благодаря наличию буферных свойств; влияют на вязкость крови и плазмы, что чрезвычайно важно для поддержания нормального уровня кровяного давления, обеспечивают гуморальный иммунитет, ибо являются антителами (иммуноглобулинами); принимают участие в свертывании крови;
 Ø служат переносчиками ряда гормонов, липидов, минеральных веществ и др. ; Ø обеспечивают процессы репарации, роста и развития различных клеток организма. Ø Трофическую функцию белки плазмы выполняют при резком или длительном ограничении поступления белков в организм. Белки плазмы крови в таких условиях распадаются с образованием аминокислот, которые используются клетками для прохождения пластических процессов.
Ø служат переносчиками ряда гормонов, липидов, минеральных веществ и др. ; Ø обеспечивают процессы репарации, роста и развития различных клеток организма. Ø Трофическую функцию белки плазмы выполняют при резком или длительном ограничении поступления белков в организм. Белки плазмы крови в таких условиях распадаются с образованием аминокислот, которые используются клетками для прохождения пластических процессов.
 Донорство n Существует обширная практика собирания донорской плазмы крови. Плазма отделяется от кровяных телец центрифугированием с помощью специального аппарата, после чего эритроциты возвращаются донору. Этот процесс называется плазмафорезом. Основателем первых пригодных для переливания банков крови принято считать Чарльза Ричарда Дрю.
Донорство n Существует обширная практика собирания донорской плазмы крови. Плазма отделяется от кровяных телец центрифугированием с помощью специального аппарата, после чего эритроциты возвращаются донору. Этот процесс называется плазмафорезом. Основателем первых пригодных для переливания банков крови принято считать Чарльза Ричарда Дрю.
 Сы воротка крови n Сыворотки получают либо путём естественного свёртывания плазмы (нативные сыворотки), либо осаждением фибриногена ионами кальция. В сыворотках сохранена большая часть антител, а за счёт отсутствия фибриногена резко увеличивается стабильность. n Сыворотку выделяют при анализе крови на инфекционные заболевания, при оценке эффективности вакцинации n Сыворотки используют в качестве лекарственных препаратов при многих инфекционных заболеваниях (столбняке, дифтерии, гриппе…) и отравлениях (яды змей, ботулотоксин…) n Сыворотки, меченые ферментами, радионуклидами и люминофорами применяют в диагностике некоторых заболеваний и в научных исследованиях.
Сы воротка крови n Сыворотки получают либо путём естественного свёртывания плазмы (нативные сыворотки), либо осаждением фибриногена ионами кальция. В сыворотках сохранена большая часть антител, а за счёт отсутствия фибриногена резко увеличивается стабильность. n Сыворотку выделяют при анализе крови на инфекционные заболевания, при оценке эффективности вакцинации n Сыворотки используют в качестве лекарственных препаратов при многих инфекционных заболеваниях (столбняке, дифтерии, гриппе…) и отравлениях (яды змей, ботулотоксин…) n Сыворотки, меченые ферментами, радионуклидами и люминофорами применяют в диагностике некоторых заболеваний и в научных исследованиях.
 КЛЕТОЧНЫЙ СОСТАВ НОРМАЛЬНОЙ КРОВИ Эритроциты Тромбоциты Лейкоциты (Красные кровяные тельца) (пластинки) (белые кровяные тельца) У женщин 3, 9 – 4, 9 х1012 У мужчин 4, 0 – 5, 2 х1012 млн. 190 – 405 х1011 3, 8 – 9, 8 х109 1/л, Из них: Базофилы 0, 5 1% Нейтрофилы 40 75% Эозинофилы 1 5% Моноциты 2 9 % Лимфоциты20 45%
КЛЕТОЧНЫЙ СОСТАВ НОРМАЛЬНОЙ КРОВИ Эритроциты Тромбоциты Лейкоциты (Красные кровяные тельца) (пластинки) (белые кровяные тельца) У женщин 3, 9 – 4, 9 х1012 У мужчин 4, 0 – 5, 2 х1012 млн. 190 – 405 х1011 3, 8 – 9, 8 х109 1/л, Из них: Базофилы 0, 5 1% Нейтрофилы 40 75% Эозинофилы 1 5% Моноциты 2 9 % Лимфоциты20 45%
 ЭРИТРОЦИТЫ n Безъядерные клетки n Диаметр – 7. 2 8 мкм n Продолжительность жизни – 100 120 дней (ежесекундно образуется около 2, 5 млн эритроцитов и такое же их количество разрушается). У собак — 107 дней, у кроликов и кошек — 68. Форма двояковогнутой линзы Развитый субмембранный компонент цитоскелета Способность к упругой деформации Высокое (30% сухой массы) содержание гемоглобина n n
ЭРИТРОЦИТЫ n Безъядерные клетки n Диаметр – 7. 2 8 мкм n Продолжительность жизни – 100 120 дней (ежесекундно образуется около 2, 5 млн эритроцитов и такое же их количество разрушается). У собак — 107 дней, у кроликов и кошек — 68. Форма двояковогнутой линзы Развитый субмембранный компонент цитоскелета Способность к упругой деформации Высокое (30% сухой массы) содержание гемоглобина n n
 n Форма двояковогнутого диска обеспечивает прохождение эритроцитов через узкие просветы капилляров. В капиллярах они движутся со скоростью 2 сантиметра в минуту, что дает им время передать кислород от гемоглобина к миоглобину. Миоглобин действует как посредник, принимая кислород у гемоглобина в крови и передавая его цитохромам в мышечных клетках. n Количество эритроцитов в крови в норме поддерживается на постоянном уровне (у человека в 1 мм³ крови 4, 5— 5 млн эритроцитов, у некоторых копытных 15, 4 млн (лама) и 13 млн (коза) эритроцитов, у пресмыкающихся — от 500 тыс. до 1, 65 млн, у хрящевых рыб — 90— 130 тыс. )
n Форма двояковогнутого диска обеспечивает прохождение эритроцитов через узкие просветы капилляров. В капиллярах они движутся со скоростью 2 сантиметра в минуту, что дает им время передать кислород от гемоглобина к миоглобину. Миоглобин действует как посредник, принимая кислород у гемоглобина в крови и передавая его цитохромам в мышечных клетках. n Количество эритроцитов в крови в норме поддерживается на постоянном уровне (у человека в 1 мм³ крови 4, 5— 5 млн эритроцитов, у некоторых копытных 15, 4 млн (лама) и 13 млн (коза) эритроцитов, у пресмыкающихся — от 500 тыс. до 1, 65 млн, у хрящевых рыб — 90— 130 тыс. )
 Гемоглобин n Железосодержащий пигмент (гем) соединенный белком (глобин) гемоглобин, который связывает кислород или углекислый газ. Основная функция эритроцитов обеспечение газообмена: доставка к тканям кислорода и удаление углекислого газа. Эритроциты могут адсорбировать на своей поверхности аминокислоты, антигены, антитела, лекарственные вещества, токсины и т. д) и транспортировать по всему организму; благодаря амфатерным свойствам гемоглобина эритроциты участвуют в поддержании РН крови.
Гемоглобин n Железосодержащий пигмент (гем) соединенный белком (глобин) гемоглобин, который связывает кислород или углекислый газ. Основная функция эритроцитов обеспечение газообмена: доставка к тканям кислорода и удаление углекислого газа. Эритроциты могут адсорбировать на своей поверхности аминокислоты, антигены, антитела, лекарственные вещества, токсины и т. д) и транспортировать по всему организму; благодаря амфатерным свойствам гемоглобина эритроциты участвуют в поддержании РН крови.
 n До 52 % массы мембраны эритроцитов составляют белки гликопротеины, которые с олигосахаридами образуют антигены групп крови. Гликопротеины мембраны содержат сиаловую кислоту, которая придает отрицательный заряд эритроцитам, отталкивающий их друг от друга.
n До 52 % массы мембраны эритроцитов составляют белки гликопротеины, которые с олигосахаридами образуют антигены групп крови. Гликопротеины мембраны содержат сиаловую кислоту, которая придает отрицательный заряд эритроцитам, отталкивающий их друг от друга.
 n В состав цитоскелета мембраны эритроцита входят n n n белки анкирин, актин, белки полосы 4. 1, 4. 2, 4. 9, тропомиозин, тропомодулин. Основой мембраны эритроцита является липидный бислой, пронизанный интегральными белками цитоскелета гликопротеинами и белком полосы 3. Последние связаны с частью белковой сети цитоскелета комплексом спектрин—актин—белок полосы 4. 1, локализованным на цитоплазматической поверхности липидного бислоя мембраны эритроцита.
n В состав цитоскелета мембраны эритроцита входят n n n белки анкирин, актин, белки полосы 4. 1, 4. 2, 4. 9, тропомиозин, тропомодулин. Основой мембраны эритроцита является липидный бислой, пронизанный интегральными белками цитоскелета гликопротеинами и белком полосы 3. Последние связаны с частью белковой сети цитоскелета комплексом спектрин—актин—белок полосы 4. 1, локализованным на цитоплазматической поверхности липидного бислоя мембраны эритроцита.
 Белки мемраны Спектрин имеет палочкообразную форму и, стыкуясь друг с другом "конец в конец", образует на внутренней поверхности плазмолеммы сетку, которая придаёт мембране эластичность и упругость. Гликофорин Интегральный белок С внешней стороны мембраны с его пептидной цепью связаны олигосахаридные остатки, в т. ч. остатки сиаловой кислоты. Они содержат ионизированные карбоксильные группы, которые придают эритроциту отрицательный заряд. Ионные каналы а) угие мембранные белки образуют ионные каналы для анионов: Cl , HCO 3 , OH . для катионов мембрана эритроцитов практически непроницаема.
Белки мемраны Спектрин имеет палочкообразную форму и, стыкуясь друг с другом "конец в конец", образует на внутренней поверхности плазмолеммы сетку, которая придаёт мембране эластичность и упругость. Гликофорин Интегральный белок С внешней стороны мембраны с его пептидной цепью связаны олигосахаридные остатки, в т. ч. остатки сиаловой кислоты. Они содержат ионизированные карбоксильные группы, которые придают эритроциту отрицательный заряд. Ионные каналы а) угие мембранные белки образуют ионные каналы для анионов: Cl , HCO 3 , OH . для катионов мембрана эритроцитов практически непроницаема.

 n Взаимодействие белкового цитоскелета с липидным бислоем мембраны обеспечивает стабильность структуры эритроцита, поведение эритроцита как упругого твердого тела при его деформации. Нековалентные межмолекулярные взаимодействия белков цитоскелета легко обеспечивают изменение размеров и формы эритроцитов при прохождении этих клеток через микроциркуляторное русло, при выходе ретикулоцитов из костного мозга в кровь — благодаря изменению расположения молекул спектрина на внутренней поверхности липидного бислоя. Увеличение соотношения холестерин—фосфолипиды в мембране увеличивает ее вязкость, уменьшает текучесть и эластичность мембраны эритроцита. В результате снижается деформируемость эритроцита. Усиление окисления ненасыщенных жирных кислот фосфолипидов мембраны перекисью водорода или супероксидными радикалами вызывает гемолиз эритроцитов (разрушение эритроцитов с выходом гемоглобина в окружающую среду). Постоянно образующиеся в эритроците антиоксиданты и др. защищают компоненты эритроцита от этого повреждения.
n Взаимодействие белкового цитоскелета с липидным бислоем мембраны обеспечивает стабильность структуры эритроцита, поведение эритроцита как упругого твердого тела при его деформации. Нековалентные межмолекулярные взаимодействия белков цитоскелета легко обеспечивают изменение размеров и формы эритроцитов при прохождении этих клеток через микроциркуляторное русло, при выходе ретикулоцитов из костного мозга в кровь — благодаря изменению расположения молекул спектрина на внутренней поверхности липидного бислоя. Увеличение соотношения холестерин—фосфолипиды в мембране увеличивает ее вязкость, уменьшает текучесть и эластичность мембраны эритроцита. В результате снижается деформируемость эритроцита. Усиление окисления ненасыщенных жирных кислот фосфолипидов мембраны перекисью водорода или супероксидными радикалами вызывает гемолиз эритроцитов (разрушение эритроцитов с выходом гемоглобина в окружающую среду). Постоянно образующиеся в эритроците антиоксиданты и др. защищают компоненты эритроцита от этого повреждения.
 n У здорового человека около 75% эритроцитов имеют диаметр 7 8 мкм (нормоциты), 10% меньше 7 мкм (микроциты) и больше 8 мкм (макроциты). Нарушение данного соотношения по диаметру эритроцитов называется анизоцитозом и может быть по типу микроцитоза или макроцитоза. Увеличение атипичных форм эритроцитов больше 10% называется пойкилоцитозом.
n У здорового человека около 75% эритроцитов имеют диаметр 7 8 мкм (нормоциты), 10% меньше 7 мкм (микроциты) и больше 8 мкм (макроциты). Нарушение данного соотношения по диаметру эритроцитов называется анизоцитозом и может быть по типу микроцитоза или макроцитоза. Увеличение атипичных форм эритроцитов больше 10% называется пойкилоцитозом.
 Атипичные эритроциты n 1. Эхиноцит ("волосатая клетка") клетка с тонкими короткими выростами. n 2. Акантоцит клетка с грубыми толстыми шипиками на поверхности. n 3. Мишеневидный эритроцит клетка с утолщением в центре. n 4. Планоцит клетка с плоскопараллельными поверхностями. n 5. Сфероцит клетка шарообразной формы. n 6. Серповидная клетки, похожие на серп
Атипичные эритроциты n 1. Эхиноцит ("волосатая клетка") клетка с тонкими короткими выростами. n 2. Акантоцит клетка с грубыми толстыми шипиками на поверхности. n 3. Мишеневидный эритроцит клетка с утолщением в центре. n 4. Планоцит клетка с плоскопараллельными поверхностями. n 5. Сфероцит клетка шарообразной формы. n 6. Серповидная клетки, похожие на серп
 Ретикулоциты n Ретикулоциты это только что вышедшие из красного костного мозга эритроциты; в цитоплазме имеют остатки органоидов, выявляющиеся при окраске специальными красителями в виде зерен и нитей, обуславли вающие сетчатый рисунок. n Ретикулоциты в течение 1 суток после выхода из красного костного мозга дозревают, теряют остатки органоидов и превращаются в зрелые эритроциты. Количество ретикулоцитов в норме 1 5%.
Ретикулоциты n Ретикулоциты это только что вышедшие из красного костного мозга эритроциты; в цитоплазме имеют остатки органоидов, выявляющиеся при окраске специальными красителями в виде зерен и нитей, обуславли вающие сетчатый рисунок. n Ретикулоциты в течение 1 суток после выхода из красного костного мозга дозревают, теряют остатки органоидов и превращаются в зрелые эритроциты. Количество ретикулоцитов в норме 1 5%.
 Жизненный цикл эритроцита n Эритроциты образуются в красном костном мозгу, функционируют в кровеносных сосудах, в среднем живут около 120 суток, стареющие и поврежденные эритроциты разрушаются в селезенке. Железо гемоглобина погибших эритроцитов доставляется моноцитами в красный костный мозг и повторно используется в новых эритроцитах.
Жизненный цикл эритроцита n Эритроциты образуются в красном костном мозгу, функционируют в кровеносных сосудах, в среднем живут около 120 суток, стареющие и поврежденные эритроциты разрушаются в селезенке. Железо гемоглобина погибших эритроцитов доставляется моноцитами в красный костный мозг и повторно используется в новых эритроцитах.
 Старение эритроцитов n Старение эритроцитов связано с уменьшением образования в эритроците количества АТФ в ходе метаболизма глюкозы в этой клетке крови. Уменьшенное образование АТФ, ее дефицит нарушает в эритроците процессы, обеспечиваемые ее энергией, — восстановление формы эритроцитов, транспорт катионов через его мембрану и защиту компонентов эритроцитов от окисления, их мембрана теряет сиаловые кислоты. Старение эритроцитов вызывает изменения мембраны эритроцитов: из дискоцитов они превращаются в эхиноциты
Старение эритроцитов n Старение эритроцитов связано с уменьшением образования в эритроците количества АТФ в ходе метаболизма глюкозы в этой клетке крови. Уменьшенное образование АТФ, ее дефицит нарушает в эритроците процессы, обеспечиваемые ее энергией, — восстановление формы эритроцитов, транспорт катионов через его мембрану и защиту компонентов эритроцитов от окисления, их мембрана теряет сиаловые кислоты. Старение эритроцитов вызывает изменения мембраны эритроцитов: из дискоцитов они превращаются в эхиноциты
 Стареющие эритроциты становятся менее эластичными, вследствие чего разрушаются внутри сосудов (внутрисосудистый гемолиз) или же становятся добычей захватывающих и разрушающих их макрофагов в селезенке, купферовских клетках печени и в костном мозге (внесосудистый или внутриклеточный гемолиз). Внутриклеточным гемолизом в сутки разрушается 80— 90 % старых эритроцитов, содержащих 6— 7 г гемоглобина, из которых освобождается в макрофагах до 30 мг железа. После отщепления от гемоглобина гем превращается в желчный пигмент билирубин, который поступает с желчью в кишечник и под влиянием микрофлоры кишечника последовательно превращается в уробилиноген, а затем в стеркобилиноген. Оба соединения выводятся из организма с калом и мочой.
Стареющие эритроциты становятся менее эластичными, вследствие чего разрушаются внутри сосудов (внутрисосудистый гемолиз) или же становятся добычей захватывающих и разрушающих их макрофагов в селезенке, купферовских клетках печени и в костном мозге (внесосудистый или внутриклеточный гемолиз). Внутриклеточным гемолизом в сутки разрушается 80— 90 % старых эритроцитов, содержащих 6— 7 г гемоглобина, из которых освобождается в макрофагах до 30 мг железа. После отщепления от гемоглобина гем превращается в желчный пигмент билирубин, который поступает с желчью в кишечник и под влиянием микрофлоры кишечника последовательно превращается в уробилиноген, а затем в стеркобилиноген. Оба соединения выводятся из организма с калом и мочой.
 Функции n Основной функцией эритроцитов является перенос кислорода из лёгких к тканям тела, и транспорт диоксида углерода (углекислого газа) в обратном направлении. n участие в регуляции кислотно щелочного равновесия; n поддерживают изотонию крови и тканей; n адсорбируют из плазмы крови аминокислоты, липиды и переносят их к тканям.
Функции n Основной функцией эритроцитов является перенос кислорода из лёгких к тканям тела, и транспорт диоксида углерода (углекислого газа) в обратном направлении. n участие в регуляции кислотно щелочного равновесия; n поддерживают изотонию крови и тканей; n адсорбируют из плазмы крови аминокислоты, липиды и переносят их к тканям.
 Лейкоциты n белые кровяные тельца, свои функции выполняют в тканях, поэтому обладают способностью передвигаться при помощи псевдоподий. Количество лейкоцитов в крови у здорового человека колеблется в пределах 4 9 х109/л. У новорожденного количество лейкоцитов составляет около 20 х109/л, в последующем постепенно и медленно снижается и достигает уровня показателя взрослых к моменту полового созревания.
Лейкоциты n белые кровяные тельца, свои функции выполняют в тканях, поэтому обладают способностью передвигаться при помощи псевдоподий. Количество лейкоцитов в крови у здорового человека колеблется в пределах 4 9 х109/л. У новорожденного количество лейкоцитов составляет около 20 х109/л, в последующем постепенно и медленно снижается и достигает уровня показателя взрослых к моменту полового созревания.
 n Среди лейкоцитов различают гранулоциты (зернистые лейкоциты) и агранулоциты (незернистые лейкоциты). Гранулоциты делятся на эозинофильные, базофильные и нейтрофильные. n По структуре ядра сегментоядерные (гранулоциты) и несегментоядерные (агранулоциты) среди гранулоцитов различают: 1. Юные ядро бобовидное или подковообразное, хроматин рыхлый (светлый), т. е. слабоконденсированный. 2. Палочкоядерные ядро палочкообразное или S образное, не сегментированное (без перетяжек), хроматин уплотнен. 3. Сегментоядерные ядро состоит из 2 4 сегментов, соединенных тонкими перемычками; сильно конденсированный.
n Среди лейкоцитов различают гранулоциты (зернистые лейкоциты) и агранулоциты (незернистые лейкоциты). Гранулоциты делятся на эозинофильные, базофильные и нейтрофильные. n По структуре ядра сегментоядерные (гранулоциты) и несегментоядерные (агранулоциты) среди гранулоцитов различают: 1. Юные ядро бобовидное или подковообразное, хроматин рыхлый (светлый), т. е. слабоконденсированный. 2. Палочкоядерные ядро палочкообразное или S образное, не сегментированное (без перетяжек), хроматин уплотнен. 3. Сегментоядерные ядро состоит из 2 4 сегментов, соединенных тонкими перемычками; сильно конденсированный.
 ОБЩИЕ СВОЙСТВА ЛЕЙКОЦИТОВ n Способность к выходу в ткани n Адгезия и миграция, способность к амебоидному движению n Хемотаксис n Участие в иммунных реакциях (в т. ч. презентация антигенов) n Активация
ОБЩИЕ СВОЙСТВА ЛЕЙКОЦИТОВ n Способность к выходу в ткани n Адгезия и миграция, способность к амебоидному движению n Хемотаксис n Участие в иммунных реакциях (в т. ч. презентация антигенов) n Активация
 Гранулы Неспецифические гранулы характерны для всех видов лейкоцитов Ø по величине сравнительно невелики (0, 4 0, 8 мкм) и Ø представляют собой разновидность лизосом: содержат гидролитические ферменты, в т. ч. кислую фосфатазу. n специфические гранулы. Каждый вид гранулоцитов содержит свой вид n нейтрофильные, n базофильные или n эозинофильные (ацидофильные, оксифильные) свойства. n в) Это определяет тинкториальные свойства n а также функциональные возможности клетки в целом.
Гранулы Неспецифические гранулы характерны для всех видов лейкоцитов Ø по величине сравнительно невелики (0, 4 0, 8 мкм) и Ø представляют собой разновидность лизосом: содержат гидролитические ферменты, в т. ч. кислую фосфатазу. n специфические гранулы. Каждый вид гранулоцитов содержит свой вид n нейтрофильные, n базофильные или n эозинофильные (ацидофильные, оксифильные) свойства. n в) Это определяет тинкториальные свойства n а также функциональные возможности клетки в целом.
 Гранулоциты n Нейтрофилы n Эозинофилы n Базофилы
Гранулоциты n Нейтрофилы n Эозинофилы n Базофилы
 Нейтрофилы n лейкоциты с мелкими (пылевидными), равномерно распределенными по цитоплазме, воспринимающие и кислые и основные красители гранулами. n У здорового человека содержание юных нейтрофилов 0 1%, палочкоядерных 3 5%, сегментоядерных 60 65%.
Нейтрофилы n лейкоциты с мелкими (пылевидными), равномерно распределенными по цитоплазме, воспринимающие и кислые и основные красители гранулами. n У здорового человека содержание юных нейтрофилов 0 1%, палочкоядерных 3 5%, сегментоядерных 60 65%.
НЕЙТРОФИЛЫ n Диаметр в мазке – 12 мкм, в тканях – до 20 мкм n Сегментированное (3 5 сегментов) ядро n Гранулы в цитоплазме
НЕЙТРОФИЛЫ n Диаметр в мазке – 12 мкм, в тканях – до 20 мкм n Сегментированное (3 5 сегментов) ядро n Гранулы в цитоплазме
 1) Ядро сегментировано(1), , Сегментация ядра облегчает миграцию нейтрофила в тканях. Сегменты соединенных тонкими перемычками (2) + у женщин иногда видна барабанная палочка (половой хроматин). n 2) Цитоплазме содержит n немногочисленные органеллы : митохондрии (5) и ЭПС (4), цитоплазма окрашивается слабо оксифильно. n " многочисленные включения специфические гранулы (зернистость) . Специфических гранул в 2 раза больше, чем неспецифических. n
1) Ядро сегментировано(1), , Сегментация ядра облегчает миграцию нейтрофила в тканях. Сегменты соединенных тонкими перемычками (2) + у женщин иногда видна барабанная палочка (половой хроматин). n 2) Цитоплазме содержит n немногочисленные органеллы : митохондрии (5) и ЭПС (4), цитоплазма окрашивается слабо оксифильно. n " многочисленные включения специфические гранулы (зернистость) . Специфических гранул в 2 раза больше, чем неспецифических. n
 n Нейтрофильные гранулы по размеру (0, 1 0, 3 мкм), n но содержатся вещества антибактериального действия n лизоцим, фагоцитины, лактоферрин, коллагеназа и другие, n фермент щелочная фосфатаза ( в отличие от кислой фосфатазы в неспецифических гранулах). n Азурофильные гранулы содержат n Протеазы (Катепсин G, эластаза) миелопероксидаза, дефензины
n Нейтрофильные гранулы по размеру (0, 1 0, 3 мкм), n но содержатся вещества антибактериального действия n лизоцим, фагоцитины, лактоферрин, коллагеназа и другие, n фермент щелочная фосфатаза ( в отличие от кислой фосфатазы в неспецифических гранулах). n Азурофильные гранулы содержат n Протеазы (Катепсин G, эластаза) миелопероксидаза, дефензины
 Свойства нейтрофилов Ø выход из крови в ткани, миграция в тканях Ø направленная миграция (хемотаксис) в очаги Ø Ø воспаления под действием хемотаксических факторов активация под действием медиаторов иммунитета и бактерий интенсивный фагоцитоз бактерий, клеточных остатков (микрофагоцитоз) способность высвобождать содержимое своих гранул во внеклеточное пространство, что приводит к гибели окружающих тканей и образованию гноя синтез множества биологически активных веществ
Свойства нейтрофилов Ø выход из крови в ткани, миграция в тканях Ø направленная миграция (хемотаксис) в очаги Ø Ø воспаления под действием хемотаксических факторов активация под действием медиаторов иммунитета и бактерий интенсивный фагоцитоз бактерий, клеточных остатков (микрофагоцитоз) способность высвобождать содержимое своих гранул во внеклеточное пространство, что приводит к гибели окружающих тканей и образованию гноя синтез множества биологически активных веществ
 n при фагоцитозе, фагоцитарная вакуоль сначала сливается со специфическими гранулами, а затем комплекс фагосома специфическая гранула сливается с неспецифическими гранулами. Таким образом, на фагоцитируемый материал сначала действуют вещества специфических гранул, которые убивают его (бактерии или клетки), а затем действуют вещества лизосом (неспецифических гранул), которые расщепляют все органические биополимеры до мономеров
n при фагоцитозе, фагоцитарная вакуоль сначала сливается со специфическими гранулами, а затем комплекс фагосома специфическая гранула сливается с неспецифическими гранулами. Таким образом, на фагоцитируемый материал сначала действуют вещества специфических гранул, которые убивают его (бактерии или клетки), а затем действуют вещества лизосом (неспецифических гранул), которые расщепляют все органические биополимеры до мономеров
 Респираторный взрыв n После стимуляции увеличивают поглощение кислорода и расходуют его с образованием Н 2 О 2 , супероксида О 2 и радикал ОН.
Респираторный взрыв n После стимуляции увеличивают поглощение кислорода и расходуют его с образованием Н 2 О 2 , супероксида О 2 и радикал ОН.
 Функции n неспецифический фагоцитоз. n участие в воспалении Повышение числа нейтрофилов в крови (нейтрофильный лейкоцитоз) свидетельствует о гнойном воспалении у больного. Сдвиг нейтрофилов влево это повышение содержания молодых форм в лейкоцитарной формуле ("омолаживание формулы") свидетельствует о том же. Сдвиг нейтрофилов вправо это понижение содержания молодых форм в лейкоцитарной формуле ("постарение формулы") свидетельствует о нарушение функций ККМ.
Функции n неспецифический фагоцитоз. n участие в воспалении Повышение числа нейтрофилов в крови (нейтрофильный лейкоцитоз) свидетельствует о гнойном воспалении у больного. Сдвиг нейтрофилов влево это повышение содержания молодых форм в лейкоцитарной формуле ("омолаживание формулы") свидетельствует о том же. Сдвиг нейтрофилов вправо это понижение содержания молодых форм в лейкоцитарной формуле ("постарение формулы") свидетельствует о нарушение функций ККМ.
 n Увеличение числа нейтрофилов, особенно незрелых форм, свидетельствует о наличии инфекции (абсцесс, аппендицит, пневмония, пиелонефрит, ангина, менингит, сепсис). Сходные изменения отмечаются при инфаркте миокарда, ожогах, отравлении свинцом, сильной кровопотере, лейкозах. При некоторых инфекциях (брюшной тиф, малярия, некоторые формы туберкулеза, гепатит, грипп, корь, краснуха) число нейтрофилов, наоборот, снижается. Уменьшение числа нейтрофилов может происходить при системной красной волчанке, воздействии радиации и токсических химических веществ (анилин, бензол, цитостатики), при некоторых анемиях и лейкозах.
n Увеличение числа нейтрофилов, особенно незрелых форм, свидетельствует о наличии инфекции (абсцесс, аппендицит, пневмония, пиелонефрит, ангина, менингит, сепсис). Сходные изменения отмечаются при инфаркте миокарда, ожогах, отравлении свинцом, сильной кровопотере, лейкозах. При некоторых инфекциях (брюшной тиф, малярия, некоторые формы туберкулеза, гепатит, грипп, корь, краснуха) число нейтрофилов, наоборот, снижается. Уменьшение числа нейтрофилов может происходить при системной красной волчанке, воздействии радиации и токсических химических веществ (анилин, бензол, цитостатики), при некоторых анемиях и лейкозах.

 ЦИТОЛОГИЧЕСКИЕ ОСОБЕННОСТИ ЭОЗИНОФИЛОВ n Диаметр 12 мкм и более (в тканях 20) n Количество эозинофилов в крови 1 5%. n Продолжительность жизни 8 14 дней n Хорошо развита гранулярная ЭПС n Сегментированное ядро n Гранулы в цитоплазме n на поверхности эозинофилов содержатся рецепторы Ig. G, Ig. E, комплемента C 3 b, C 4, C 1 s, C 3 a, C 5 a и др.
ЦИТОЛОГИЧЕСКИЕ ОСОБЕННОСТИ ЭОЗИНОФИЛОВ n Диаметр 12 мкм и более (в тканях 20) n Количество эозинофилов в крови 1 5%. n Продолжительность жизни 8 14 дней n Хорошо развита гранулярная ЭПС n Сегментированное ядро n Гранулы в цитоплазме n на поверхности эозинофилов содержатся рецепторы Ig. G, Ig. E, комплемента C 3 b, C 4, C 1 s, C 3 a, C 5 a и др.
 ГРАНУЛЫ ЭОЗИНОФИЛОВ Специфические: n n а) Эозинофильные гранулы - крупные (0, 5 - 1, 5 мкм), овальной или полигональной формы. n б) Содержат n щелочной белок, образующий пластинчатые кристаллоидные структуры. n в) Являются разновидностью пероксисом: в них происходит окислительное дезактивирование гистамина и серотонина, n сопровождаемое образованием Н 2 О 2. n n г) Содержат также фермент антипаразитарный белок, пероксидазу, которая катализирует окисление веществ пероксидом водорода (Н 2 О 2), катионный белок эозинофилов
ГРАНУЛЫ ЭОЗИНОФИЛОВ Специфические: n n а) Эозинофильные гранулы - крупные (0, 5 - 1, 5 мкм), овальной или полигональной формы. n б) Содержат n щелочной белок, образующий пластинчатые кристаллоидные структуры. n в) Являются разновидностью пероксисом: в них происходит окислительное дезактивирование гистамина и серотонина, n сопровождаемое образованием Н 2 О 2. n n г) Содержат также фермент антипаразитарный белок, пероксидазу, которая катализирует окисление веществ пероксидом водорода (Н 2 О 2), катионный белок эозинофилов
 n оксифильные гранулы при очень большом увеличении: n сверху справа поперечный срез гранулы, n а снизу слева продольный срез. гранула имеет цилиндрическую форму n и содержит кристаллоид плотную пластинчатую структуру тоже цилиндрической формы. n
n оксифильные гранулы при очень большом увеличении: n сверху справа поперечный срез гранулы, n а снизу слева продольный срез. гранула имеет цилиндрическую форму n и содержит кристаллоид плотную пластинчатую структуру тоже цилиндрической формы. n
 Свойства и функции эозинофилов n n n n n свойства выход из крови в ткани и в просветы внутренних органов миграция в тканях и на поверхности слизистых оболочек внутренних органов способность высвобождать содержимое гранул в окружающее пространство (дегрануляция) слабый фагоцитоз, при котором специфические гранулы могут сливаться с лизосомами и фагосомами, но этот процесс не так активен как у нейтрофилов эозинофилы способны прикрепляться к паразитам, локально высвобождать содержимое гранул и вводить из содержимое в цитоплазму паразита функции: обусловлены действием веществ гранул, и секрецией ряда биологически активных веществ, не входящих в состав гранул, таких как тромбоцит активирующий фактор, тромбоксан, лейкотриены Уничтожение паразитов Участие в аллергических и воспалительных процессах путем разрушения ферментом гистаминазой избытка медиатора аллергических реакций гистамина.
Свойства и функции эозинофилов n n n n n свойства выход из крови в ткани и в просветы внутренних органов миграция в тканях и на поверхности слизистых оболочек внутренних органов способность высвобождать содержимое гранул в окружающее пространство (дегрануляция) слабый фагоцитоз, при котором специфические гранулы могут сливаться с лизосомами и фагосомами, но этот процесс не так активен как у нейтрофилов эозинофилы способны прикрепляться к паразитам, локально высвобождать содержимое гранул и вводить из содержимое в цитоплазму паразита функции: обусловлены действием веществ гранул, и секрецией ряда биологически активных веществ, не входящих в состав гранул, таких как тромбоцит активирующий фактор, тромбоксан, лейкотриены Уничтожение паразитов Участие в аллергических и воспалительных процессах путем разрушения ферментом гистаминазой избытка медиатора аллергических реакций гистамина.
 Эозинофильный лейкоцитоз (эозинофилия) частый симптом при различных аллергических заболеваниях. Умеренная эозинофилия может быть при ожогах, обморожениях, экземе, крапивнице. n Эозинофилию наблюдается при: паразитарных болезнях (трихинеллез, аскаридоз, эхинококков и др. ), ревматизме, при длительном применении антибиотиков. n Небольшая эозинофилия может быть при хроническом миелолейкозе, лимфогранулематозе, злокачественных новообразованиях, туберкулезе, эмфиземе легких. n Эозинофилия при воспалительных и гнойно септических процессах на фоне лимфоцитоза и незначительного ядерного сдвига нейтрофилов является предвестником благоприятного исхода заболевания n n Эозинопения и анэозинофилия наблюдается на высоте некоторых острых инфекционных и вирусных заболеваний, интоксикаций, в агональном состоянии, на стадии истощения, стрессовой реакции.
Эозинофильный лейкоцитоз (эозинофилия) частый симптом при различных аллергических заболеваниях. Умеренная эозинофилия может быть при ожогах, обморожениях, экземе, крапивнице. n Эозинофилию наблюдается при: паразитарных болезнях (трихинеллез, аскаридоз, эхинококков и др. ), ревматизме, при длительном применении антибиотиков. n Небольшая эозинофилия может быть при хроническом миелолейкозе, лимфогранулематозе, злокачественных новообразованиях, туберкулезе, эмфиземе легких. n Эозинофилия при воспалительных и гнойно септических процессах на фоне лимфоцитоза и незначительного ядерного сдвига нейтрофилов является предвестником благоприятного исхода заболевания n n Эозинопения и анэозинофилия наблюдается на высоте некоторых острых инфекционных и вирусных заболеваний, интоксикаций, в агональном состоянии, на стадии истощения, стрессовой реакции.
 ЦИТОЛОГИЧЕСКИЕ ОСОБЕННОСТИ БАЗОФИЛОВ n Время жизни в кровотоке – 1 2 суток n Размер – 10 12 мкм n Ядро трехдольное, часто S образное n Гранулы в цитоплазме
ЦИТОЛОГИЧЕСКИЕ ОСОБЕННОСТИ БАЗОФИЛОВ n Время жизни в кровотоке – 1 2 суток n Размер – 10 12 мкм n Ядро трехдольное, часто S образное n Гранулы в цитоплазме

 ГРАНУЛЫ БАЗОФИЛОВ Специфические гранулы: Содержат n протеогликаны (гепарансульфаты и хондроитинсульфаты) n гистамин медиатор аллергических реакций, n гепарин противосвертывающее вещество. n пероксидазу n медиаторы воспаления
ГРАНУЛЫ БАЗОФИЛОВ Специфические гранулы: Содержат n протеогликаны (гепарансульфаты и хондроитинсульфаты) n гистамин медиатор аллергических реакций, n гепарин противосвертывающее вещество. n пероксидазу n медиаторы воспаления
 n свойства: n выход из крови в ткани, миграция в тканях n способность высвобождать содержимое гранул в окружающее межклеточное пространство (дегрануляция) n слабый фагоцитоз n высвобождение биологически активных веществ, не входящих в состав гранул n поглощение гистамина и серотонина из окружающих тканей
n свойства: n выход из крови в ткани, миграция в тканях n способность высвобождать содержимое гранул в окружающее межклеточное пространство (дегрануляция) n слабый фагоцитоз n высвобождение биологически активных веществ, не входящих в состав гранул n поглощение гистамина и серотонина из окружающих тканей
 Функции: n Дегрануляция при действии аллергенов n участие в аллергических реакциях организма, выделяя медиатор аллергических реакций гистамин (гистамин повышает проницаемость стенок кровеносных сосудов, тем самым облегчает выход остальных лейкоцитов из кровеносных сосудов в ткани для борьбы с антигенами), n снижают свертываемость крови, вырабатывая гепарин.
Функции: n Дегрануляция при действии аллергенов n участие в аллергических реакциях организма, выделяя медиатор аллергических реакций гистамин (гистамин повышает проницаемость стенок кровеносных сосудов, тем самым облегчает выход остальных лейкоцитов из кровеносных сосудов в ткани для борьбы с антигенами), n снижают свертываемость крови, вырабатывая гепарин.

 Незернистые лейкоциты n относятся моноциты и лимфоциты. Так как у агранулоцитов ядра несегментируются их еще называют мононуклеарами. Хотя эти лейкоциты и называются незернистыми, они могут содержать в цитоплазме неспецифические гранулы.
Незернистые лейкоциты n относятся моноциты и лимфоциты. Так как у агранулоцитов ядра несегментируются их еще называют мононуклеарами. Хотя эти лейкоциты и называются незернистыми, они могут содержать в цитоплазме неспецифические гранулы.
 ЦИТОЛОГИЧЕСКИЕ ОСОБЕННОСТИ ЛИМФОЦИТОВ n Продолжительность n n n жизни – от месяца до нескольких лет Размер клетки – 4, 5 10 мкм Округлое несегментированное ядро. Хроматин в ядре малых лимфоцитов сильно конденсирован, у средних лимфоцитов умеренно конденсирован, а у больших лимфоцитов слабо конденсирован. Слабое развитие органоидов клетки Цитоплазма в виде узкого ободка, светлоголубая. рецепторы для антигенов, медиаторов иммунитета, гормонов и ряда биологически активных веществ
ЦИТОЛОГИЧЕСКИЕ ОСОБЕННОСТИ ЛИМФОЦИТОВ n Продолжительность n n n жизни – от месяца до нескольких лет Размер клетки – 4, 5 10 мкм Округлое несегментированное ядро. Хроматин в ядре малых лимфоцитов сильно конденсирован, у средних лимфоцитов умеренно конденсирован, а у больших лимфоцитов слабо конденсирован. Слабое развитие органоидов клетки Цитоплазма в виде узкого ободка, светлоголубая. рецепторы для антигенов, медиаторов иммунитета, гормонов и ряда биологически активных веществ
 Классификация n по морфологии лимфоциты делятся на n Малые – 4. 5 6 мкм Средние – 7 10 мкм Большие – 10 18 мкм
Классификация n по морфологии лимфоциты делятся на n Малые – 4. 5 6 мкм Средние – 7 10 мкм Большие – 10 18 мкм
 n Лимфоциты имеют общую морфологическую характеристику, однако их функции, поверхностные CD (от claster differenciation) маркеры, индивидуальное (клональное) происхождение, различны. n По наличию поверхностных CD маркеров лимфоциты разделяют на функционально различные популяции и субпопуляции, прежде всего на Т- (тимусзависимые, прошедшие первичную дифференцировку в тимусе) лимфоциты и В – (bursa зависимые, прошедшие созревание в сумке Фабрициуса у птиц или его аналогах у млекопитающих) лимфоциты.
n Лимфоциты имеют общую морфологическую характеристику, однако их функции, поверхностные CD (от claster differenciation) маркеры, индивидуальное (клональное) происхождение, различны. n По наличию поверхностных CD маркеров лимфоциты разделяют на функционально различные популяции и субпопуляции, прежде всего на Т- (тимусзависимые, прошедшие первичную дифференцировку в тимусе) лимфоциты и В – (bursa зависимые, прошедшие созревание в сумке Фабрициуса у птиц или его аналогах у млекопитающих) лимфоциты.
 ФУНКЦИИ ЛИМФОЦИТОВ n Центральная роль в иммунных реакциях n Синтез антител n Иммунная память n Синтез интерлейкинов n Регуляция иммунного ответа
ФУНКЦИИ ЛИМФОЦИТОВ n Центральная роль в иммунных реакциях n Синтез антител n Иммунная память n Синтез интерлейкинов n Регуляция иммунного ответа
 В-лимфоциты В лимфоциты дифференцируются в костном мозгу и групповых лимфатических фолликулах. Обеспечивают гуморальный иммунитет, получая от макрофагов переработанную информацию о поступившем в организм антигене. В лимфоциты начинают пролиферацию, после чего дифференцируются в плазмоциты и начинают вырабатывать специфические антитела (против поступившего в организм антигена. Среди всех лимфоцитов составляют 20 25%.
В-лимфоциты В лимфоциты дифференцируются в костном мозгу и групповых лимфатических фолликулах. Обеспечивают гуморальный иммунитет, получая от макрофагов переработанную информацию о поступившем в организм антигене. В лимфоциты начинают пролиферацию, после чего дифференцируются в плазмоциты и начинают вырабатывать специфические антитела (против поступившего в организм антигена. Среди всех лимфоцитов составляют 20 25%.
 Происхождение n Образование В клеток у плода происходит в печени, в дальнейшем в костном мозге. Процесс созревания В клеток осуществляется в две стадии антиген – независимую и антиген – зависимую.
Происхождение n Образование В клеток у плода происходит в печени, в дальнейшем в костном мозге. Процесс созревания В клеток осуществляется в две стадии антиген – независимую и антиген – зависимую.
 n Антиген -независимая фаза. В лимфоцит в процессе созревания проходит стадию пре- В- лимфоцита-активно пролиферирующей клетки, имеющей цитоплазменные H цепи типа C µ (т. е. Ig. M). Следующая стадия незрелый В- лимфоцит характеризуется появлением мембранного (рецепторного) Ig. M на поверхности. Конечная стадия антигеннезависимой дифференцировки образование зрелого В- лимфоцита, который может иметь два мембранных рецептора с одинаковой антигенной специфичностью (изотипа) – Ig. M и Ig. D. Зрелые В лимфоциты покидают костный мозг и заселяют селезенку, лимфоузлы и другие скопления лимфоидной ткани, где их развитие задерживается до встречи со “своим” антигеном, т. е. до осуществления антиген зависимой дифференцировки.
n Антиген -независимая фаза. В лимфоцит в процессе созревания проходит стадию пре- В- лимфоцита-активно пролиферирующей клетки, имеющей цитоплазменные H цепи типа C µ (т. е. Ig. M). Следующая стадия незрелый В- лимфоцит характеризуется появлением мембранного (рецепторного) Ig. M на поверхности. Конечная стадия антигеннезависимой дифференцировки образование зрелого В- лимфоцита, который может иметь два мембранных рецептора с одинаковой антигенной специфичностью (изотипа) – Ig. M и Ig. D. Зрелые В лимфоциты покидают костный мозг и заселяют селезенку, лимфоузлы и другие скопления лимфоидной ткани, где их развитие задерживается до встречи со “своим” антигеном, т. е. до осуществления антиген зависимой дифференцировки.
 n Антиген-зависимая дифференцировка включает активацию, пролиферацию и дифференцировку В клеток в плазматические клетки и В клетки памяти. Активация осуществляется различными путями, что зависит от свойств антигенов и участия других клеток (макрофагов, Т хелперов). Большинство антигенов, индуцирующих синтез антител, для индукции иммунного ответа требуют участия Т клеток тимус- зависимые антигены. Тимус- независимые антигены (ЛПС, высокомолекулярные синтетические полимеры) способны стимулировать синтез антител без помощи Т лимфоцитов.
n Антиген-зависимая дифференцировка включает активацию, пролиферацию и дифференцировку В клеток в плазматические клетки и В клетки памяти. Активация осуществляется различными путями, что зависит от свойств антигенов и участия других клеток (макрофагов, Т хелперов). Большинство антигенов, индуцирующих синтез антител, для индукции иммунного ответа требуют участия Т клеток тимус- зависимые антигены. Тимус- независимые антигены (ЛПС, высокомолекулярные синтетические полимеры) способны стимулировать синтез антител без помощи Т лимфоцитов.
 n В цитоплазме покоящихся B клеток отсутствуют гранулы, но имеются рассеянные рибосомы и канальцы шероховатого эндоплазматического ретикулума. На поверхности каждого лимфоцита экспрессируется около ста тысяч молекул рецепторов. Встретив и распознав антиген, соответствующий структуре антигенраспознающего рецептора B клетки размножаются и дифференцируются в плазматические клетки, которые образуют и выделяют в растворимой форме большие количества таких рецепторных молекул антител.
n В цитоплазме покоящихся B клеток отсутствуют гранулы, но имеются рассеянные рибосомы и канальцы шероховатого эндоплазматического ретикулума. На поверхности каждого лимфоцита экспрессируется около ста тысяч молекул рецепторов. Встретив и распознав антиген, соответствующий структуре антигенраспознающего рецептора B клетки размножаются и дифференцируются в плазматические клетки, которые образуют и выделяют в растворимой форме большие количества таких рецепторных молекул антител.
 Иммуноглобулины n n n Иммуноглобулины – белки сыворотки крови и других жидкостей организма, которые действуют как антитела, связывающиеся с антигенами и обезвреживающие их. Известно 5 классов иммуноглобулинов человека (Ig. I, Ig. M, Ig. A, Ig. D, Ig. E), Ig. I около 70 %. В основном выполняют противобактериальные функции и образуют антитела против полисахаридов бактериальных оболочек, а также противорезусные антитела. Ig. M около 10 % – наиболее древние, синтезируются на ранних стадиях иммунного ответа на большинство антигенов. К этому классу относятся антитела против полисахаридов микроорганизмов и вирусов и др. Ig. D составляют менее 1 %. Увеличиваются при некоторых инфекционных заболеваниях, остеомиелите, бронхиальной астме и т. п. Ig. Е, или реагины менее 0, 5%. Ig. E играют роль пускового механизма в развертывании аллергических реакций немедленного типа. Связываясь в комплекс с аллергеном, Ig. E вызывают выброс в организм медиаторов аллергических реакций (гистамина, серотонина и др. ) Ig. A около 20 %. Против вирусов, инсулина (при сахарном диабете), тиреоглобулина (при хроническом тиреоидите). Антитела класса А нейтрализуют вирусы, обезвреживают бактерии, предупреждают фиксацию микроорганизмов на клетках эпителиальной поверхности слизистых оболочек.
Иммуноглобулины n n n Иммуноглобулины – белки сыворотки крови и других жидкостей организма, которые действуют как антитела, связывающиеся с антигенами и обезвреживающие их. Известно 5 классов иммуноглобулинов человека (Ig. I, Ig. M, Ig. A, Ig. D, Ig. E), Ig. I около 70 %. В основном выполняют противобактериальные функции и образуют антитела против полисахаридов бактериальных оболочек, а также противорезусные антитела. Ig. M около 10 % – наиболее древние, синтезируются на ранних стадиях иммунного ответа на большинство антигенов. К этому классу относятся антитела против полисахаридов микроорганизмов и вирусов и др. Ig. D составляют менее 1 %. Увеличиваются при некоторых инфекционных заболеваниях, остеомиелите, бронхиальной астме и т. п. Ig. Е, или реагины менее 0, 5%. Ig. E играют роль пускового механизма в развертывании аллергических реакций немедленного типа. Связываясь в комплекс с аллергеном, Ig. E вызывают выброс в организм медиаторов аллергических реакций (гистамина, серотонина и др. ) Ig. A около 20 %. Против вирусов, инсулина (при сахарном диабете), тиреоглобулина (при хроническом тиреоидите). Антитела класса А нейтрализуют вирусы, обезвреживают бактерии, предупреждают фиксацию микроорганизмов на клетках эпителиальной поверхности слизистых оболочек.
 Т-лимфоциты n При развитии специфического иммунного ответа Т-лимфоциты в лимфатических узлах, селезенке и лимфоидных тканях выполняют секреторные и эффекторные функции. n Активированные Т-лимфоциты продуцируют и секретируют молекулы цитокинов. Цитокины связываются со специфическими рецепторами на поверхности клеток мишеней. Соединение цитокина с его рецептором порождает сигнал активации, который передается к ядру клетки мишени, где начинают функционировать определенные гены, контролирующие функции клеток. Таким образом, Т лимфоциты своими продуктами цитокинами контролируют процессы пролиферации, дифференцировки и функциональную активность макрофагов, дендритных клеток, других Т-лимфоцитов, Влимфоцитов.
Т-лимфоциты n При развитии специфического иммунного ответа Т-лимфоциты в лимфатических узлах, селезенке и лимфоидных тканях выполняют секреторные и эффекторные функции. n Активированные Т-лимфоциты продуцируют и секретируют молекулы цитокинов. Цитокины связываются со специфическими рецепторами на поверхности клеток мишеней. Соединение цитокина с его рецептором порождает сигнал активации, который передается к ядру клетки мишени, где начинают функционировать определенные гены, контролирующие функции клеток. Таким образом, Т лимфоциты своими продуктами цитокинами контролируют процессы пролиферации, дифференцировки и функциональную активность макрофагов, дендритных клеток, других Т-лимфоцитов, Влимфоцитов.
 Т-хелперы (помощники) n несут на поверхности маркер CD 4 и в основном "помогают" в осуществлении иммунного ответа или индуцируют его n Одни T клетки участвуют в регуляции дифференцировки B лимфоцитов и образования антител. n Другие взаимодействуют с фагоцитами, помогая им в разрушении микробных клеток. n участвуют в гуморальном иммунитете: идентифицируют "свое" или "чужое", посылают предварительный химический сигнал В лимфоцитам о поступлении в организм антигена.
Т-хелперы (помощники) n несут на поверхности маркер CD 4 и в основном "помогают" в осуществлении иммунного ответа или индуцируют его n Одни T клетки участвуют в регуляции дифференцировки B лимфоцитов и образования антител. n Другие взаимодействуют с фагоцитами, помогая им в разрушении микробных клеток. n участвуют в гуморальном иммунитете: идентифицируют "свое" или "чужое", посылают предварительный химический сигнал В лимфоцитам о поступлении в организм антигена.
 Т-супрессоры (подавители) n Имеют рецепторы CD 11, CD 8. n подавляют чрезмерную пролиферацию В лимфоцитов при поступлении в организм антигена и тем самым предотвращают гиперэргическую реакцию при иммунном ответе. n способны подавить иммунный ответ либо путем прямого цитотоксического воздействия на антигенпрезентирующие клетки, либо путем выделения "супрессивных" растворимых белков цитокинов n либо путем передачи сигнала отрицательной регуляции.
Т-супрессоры (подавители) n Имеют рецепторы CD 11, CD 8. n подавляют чрезмерную пролиферацию В лимфоцитов при поступлении в организм антигена и тем самым предотвращают гиперэргическую реакцию при иммунном ответе. n способны подавить иммунный ответ либо путем прямого цитотоксического воздействия на антигенпрезентирующие клетки, либо путем выделения "супрессивных" растворимых белков цитокинов n либо путем передачи сигнала отрицательной регуляции.
 Т-киллеры (цитотоксические) n обеспечивают клеточный иммунитет, т. е. уничтожают микроорганизмы, а также свои мутантные клетки (опухолевые, трансплантант); имеют специфический рецептор CD 8, n Т киллеры распознают и контактируют с антигеном при помощи специфических рецепторов. n После контакта Т лимфоциты отходят от чужеродной клетки, но оставляют на поверхности этой клетки небольшой фрагмент своей цитолеммы (главная роль здесь принадлежит перфорину (цитолизину). Перфорин встраивается в мембрану клетки мишени и образует трансмембранные поры) на этом участке резко повышается проницаемость цитолеммы чужеродной клетки для ионов натрия и они начинают поступать в клетку, по закону осмоса вслед за натрием в клетку поступает и вода в результате чужеродная клетка разбухает и в конце концов цитолемма не выдерживает и разрывается, клетка погибает.
Т-киллеры (цитотоксические) n обеспечивают клеточный иммунитет, т. е. уничтожают микроорганизмы, а также свои мутантные клетки (опухолевые, трансплантант); имеют специфический рецептор CD 8, n Т киллеры распознают и контактируют с антигеном при помощи специфических рецепторов. n После контакта Т лимфоциты отходят от чужеродной клетки, но оставляют на поверхности этой клетки небольшой фрагмент своей цитолеммы (главная роль здесь принадлежит перфорину (цитолизину). Перфорин встраивается в мембрану клетки мишени и образует трансмембранные поры) на этом участке резко повышается проницаемость цитолеммы чужеродной клетки для ионов натрия и они начинают поступать в клетку, по закону осмоса вслед за натрием в клетку поступает и вода в результате чужеродная клетка разбухает и в конце концов цитолемма не выдерживает и разрывается, клетка погибает.
 Нормальные киллеры n или NK (от англ. natural killer ) это большие зернистые лимфоциты: основная часть обильной цитоплазмы содержит несколько митохондрий, свободные рибосомы с отдельными элементами шероховатого эндоплазматического ретикулума, аппарат Гольджи и характерные электроноплотные гранулы, связанные с мембраной. Большие зернистые лимфоциты с активностью нормальных киллеров выполняют цитотоксические функции, также как и цитотоксические T лимфоциты
Нормальные киллеры n или NK (от англ. natural killer ) это большие зернистые лимфоциты: основная часть обильной цитоплазмы содержит несколько митохондрий, свободные рибосомы с отдельными элементами шероховатого эндоплазматического ретикулума, аппарат Гольджи и характерные электроноплотные гранулы, связанные с мембраной. Большие зернистые лимфоциты с активностью нормальных киллеров выполняют цитотоксические функции, также как и цитотоксические T лимфоциты
 n Они происходят, в основном, из больших гранулярных лимфоцитов (БГЛ). Несмотря на то, что НК морфологически напоминают лимфоциты их гистогенетическая связь с Т или В лимфоцитами не установлена. n НК не имеют антигенраспознающих рецепторов, не увеличиваются количественно после взаимодействия с чужеродным (например, вирусным) антигеном и не способны к формированию иммунологической памяти. При этом их активность повышается под влиянием цитокинов Т клеток и, в первую очередь, гамма интерферона. n Одной из характеристик НК является наличие Fc рецептора.
n Они происходят, в основном, из больших гранулярных лимфоцитов (БГЛ). Несмотря на то, что НК морфологически напоминают лимфоциты их гистогенетическая связь с Т или В лимфоцитами не установлена. n НК не имеют антигенраспознающих рецепторов, не увеличиваются количественно после взаимодействия с чужеродным (например, вирусным) антигеном и не способны к формированию иммунологической памяти. При этом их активность повышается под влиянием цитокинов Т клеток и, в первую очередь, гамма интерферона. n Одной из характеристик НК является наличие Fc рецептора.
 Кооперация клеток в иммунном ответе. n n n n n В формировании иммунного ответа включаются все звенья иммунной системы макрофагов, Т и В лимфоцитов, комплемента, интерферонов и главная система гистосовместимости. В кратком виде можно выделить следующие этапы. 1. Поглощение и процессинг антигена макрофагом. 2. Представление процессированного антигена макрофагом с помощью белка главной системы гистосовместимости класса 2 (МНС класса 2) Т хелперам. 3. Узнавание антигена Т хелперами и их активация. 4. Узнавание антигена и активация В лимфоцитов. 5. Дифференциация В лимфоцитов в плазматические клетки, синтез антител. 6. Взаимодействие антител с антигеном, активация систем комплемента и макрофагов, интерферонов. 7. Представление при участии белков МНС класса 1 чужеродных антигенов Т киллерам, разрушение инфицированных чужеродными антигенами клеток Т киллерами. 8. Индукция Т и В клеток иммунной памяти, способных специфически распознавать антиген и участвовать во вторичном иммунном ответе (антигенстимулированные лимфоциты).
Кооперация клеток в иммунном ответе. n n n n n В формировании иммунного ответа включаются все звенья иммунной системы макрофагов, Т и В лимфоцитов, комплемента, интерферонов и главная система гистосовместимости. В кратком виде можно выделить следующие этапы. 1. Поглощение и процессинг антигена макрофагом. 2. Представление процессированного антигена макрофагом с помощью белка главной системы гистосовместимости класса 2 (МНС класса 2) Т хелперам. 3. Узнавание антигена Т хелперами и их активация. 4. Узнавание антигена и активация В лимфоцитов. 5. Дифференциация В лимфоцитов в плазматические клетки, синтез антител. 6. Взаимодействие антител с антигеном, активация систем комплемента и макрофагов, интерферонов. 7. Представление при участии белков МНС класса 1 чужеродных антигенов Т киллерам, разрушение инфицированных чужеродными антигенами клеток Т киллерами. 8. Индукция Т и В клеток иммунной памяти, способных специфически распознавать антиген и участвовать во вторичном иммунном ответе (антигенстимулированные лимфоциты).
 Моноциты Крупные лейкоциты, диаметром 12 15 и более мкм. Ядро несегментировано, бобовидной или подковообразной формы с умеренно конденсированным хроматином. Цитоплазма может содержать одиночные азурофильные гранулы. Развит КГ, лизосом, митохондрий. Клетка активно передвигается при помощи псевдоподий. В норме содержание в крови 6 8%.
Моноциты Крупные лейкоциты, диаметром 12 15 и более мкм. Ядро несегментировано, бобовидной или подковообразной формы с умеренно конденсированным хроматином. Цитоплазма может содержать одиночные азурофильные гранулы. Развит КГ, лизосом, митохондрий. Клетка активно передвигается при помощи псевдоподий. В норме содержание в крови 6 8%.
 n Всегда присутствуют в больших количествах в лимфатических узлах, стенках альвеол и синусах печени, селезенки и костного мозга . Моноциты также являются предшественниками клеток Лангерганса, клеток микроглии и других клеток, способных к переработке и представлению антигена. В отличие от В и Т лимфоцитов, макрофаги и моноциты не способны к специфическому распознаванию антигена.
n Всегда присутствуют в больших количествах в лимфатических узлах, стенках альвеол и синусах печени, селезенки и костного мозга . Моноциты также являются предшественниками клеток Лангерганса, клеток микроглии и других клеток, способных к переработке и представлению антигена. В отличие от В и Т лимфоцитов, макрофаги и моноциты не способны к специфическому распознаванию антигена.
 свойства: n выход из кровеносных сосудов в окружающие n n n ткани или на поверхность слизистых оболочек и дифференцировка в макрофаги миграция в тканях или на поверхности слизистых эндоцитоз способность к распластыванию секреция множества биологически активных веществ процессинг и представление антигенов
свойства: n выход из кровеносных сосудов в окружающие n n n ткани или на поверхность слизистых оболочек и дифференцировка в макрофаги миграция в тканях или на поверхности слизистых эндоцитоз способность к распластыванию секреция множества биологически активных веществ процессинг и представление антигенов
 Функции: n фагоцитоз и переваривание микроорганизмов, инородных частиц и продуктов распада собственных тканей. Выходя из кровеносных сосудов в ткани моноциты превращаются в макрофаги n • участие в гуморальном иммунитете получают от Т хелперов информацию об антигене и после переработки передают ее В лимфоцитам; • вырабатывают противовирусный белок интерферон и противомикробный белок лизоцим; • вырабатывают КСФ (колониестимулирующий фактор), регулирующий гранулоцитопоэз. • синтез эндогенных пирогенов, приводящих к повышению температуры тела
Функции: n фагоцитоз и переваривание микроорганизмов, инородных частиц и продуктов распада собственных тканей. Выходя из кровеносных сосудов в ткани моноциты превращаются в макрофаги n • участие в гуморальном иммунитете получают от Т хелперов информацию об антигене и после переработки передают ее В лимфоцитам; • вырабатывают противовирусный белок интерферон и противомикробный белок лизоцим; • вырабатывают КСФ (колониестимулирующий фактор), регулирующий гранулоцитопоэз. • синтез эндогенных пирогенов, приводящих к повышению температуры тела
 Соотношение лейкоцитов n К моменту рождения содержание нейтрофилов и лимфоцитов соответственно около 65% и 25% (т. е. как у взрослых), в последующем количество нейтрофилов уменьшается, а лимфоцитов увеличивается и на 4 й день жизни составляют по 45%; в течение 1 го года жизни эта тенденция продолжается и к 2 годам содержание нейтрофилов снижается до 25%, а лимфоцитов повышается до 45%. В дальнейшем количество нейтрофилов начинает повышаться, а лимфоцитов наоборот, снижаться и к 4 м годам они опять составляют по 45%, и наконец, к моменту полового созревания показатели достигают уровня взрослых.
Соотношение лейкоцитов n К моменту рождения содержание нейтрофилов и лимфоцитов соответственно около 65% и 25% (т. е. как у взрослых), в последующем количество нейтрофилов уменьшается, а лимфоцитов увеличивается и на 4 й день жизни составляют по 45%; в течение 1 го года жизни эта тенденция продолжается и к 2 годам содержание нейтрофилов снижается до 25%, а лимфоцитов повышается до 45%. В дальнейшем количество нейтрофилов начинает повышаться, а лимфоцитов наоборот, снижаться и к 4 м годам они опять составляют по 45%, и наконец, к моменту полового созревания показатели достигают уровня взрослых.

 Тромбоциты, кровяные пластинки n В норме содержание кровяных пластинок 200 400 х109/л. мелкие фрагменты мегакариоцитов. Диаметр 2 3 мкм; n Увеличение числа тромбоцитов «тромбоцитоз» , уменьшение — «тромбоцитопения» . В естественных условиях число тромбоцитов подвержено значительным колебаниям (количество их возрастает при болевом раздражении, физической нагрузке, стрессе).
Тромбоциты, кровяные пластинки n В норме содержание кровяных пластинок 200 400 х109/л. мелкие фрагменты мегакариоцитов. Диаметр 2 3 мкм; n Увеличение числа тромбоцитов «тромбоцитоз» , уменьшение — «тромбоцитопения» . В естественных условиях число тромбоцитов подвержено значительным колебаниям (количество их возрастает при болевом раздражении, физической нагрузке, стрессе).
 n ядра нет; представляют собой кусочки цитоплазмы, где имеются элементы комплекса Гольджи и гладкого ЭПР митохондрии, рибосомы, включения гликогена, микротрубочки, микрофиламенты, есть ферменты гликолиза, пероксисомы, а также несколько типов гранул; n на мембране имеются рецепторы для факторов свертывания крови
n ядра нет; представляют собой кусочки цитоплазмы, где имеются элементы комплекса Гольджи и гладкого ЭПР митохондрии, рибосомы, включения гликогена, микротрубочки, микрофиламенты, есть ферменты гликолиза, пероксисомы, а также несколько типов гранул; n на мембране имеются рецепторы для факторов свертывания крови
 Электронограмма n В центральной части тромбоцит содержит n грануломер выраженную зернистость, которая представлена гранулами (1) нескольких видов, n глыбками гликогена (2), n ЭПС (3), митохондриями (4) и является азурофильной n Периферическая часть тромбоцита (6) n гомогенный гиаломер, который окрашивается по разному в зависимости от возраста тромбоцита.
Электронограмма n В центральной части тромбоцит содержит n грануломер выраженную зернистость, которая представлена гранулами (1) нескольких видов, n глыбками гликогена (2), n ЭПС (3), митохондриями (4) и является азурофильной n Периферическая часть тромбоцита (6) n гомогенный гиаломер, который окрашивается по разному в зависимости от возраста тромбоцита.
 Гранулы n альфа-гранулы содержат: n гликопротеины (фибронектин, фибриноген, фактор Виллебранда) n n n белки, связывающие гепарин (фактор 4 тромбоцитов регулирует проницаемость сосудов, выход кальция из кости, хемотаксис нейтрофилов и эозинофилов, нейтрализует гепарин b тромбоглобулин факторы роста (тромбрцитарный фактор роста трансформирующий фактор роста b) факторы свертывания и тромбоспондин (тромбоспондин усиливает адгезию и агрегацию тромбоцитов; тромбопластин, фактор V, GMP 140 белок семейства селектинов, рецептор адгезии) на внутренней поверхности мембраны имеются рецепторы для факторов свертывания дельта-гранулы содержат: АДФ, АТФ, ионы кальция, серотонин, гистамин. лямбда-гранулы или азурофильные гранулы, или лизосомы:
Гранулы n альфа-гранулы содержат: n гликопротеины (фибронектин, фибриноген, фактор Виллебранда) n n n белки, связывающие гепарин (фактор 4 тромбоцитов регулирует проницаемость сосудов, выход кальция из кости, хемотаксис нейтрофилов и эозинофилов, нейтрализует гепарин b тромбоглобулин факторы роста (тромбрцитарный фактор роста трансформирующий фактор роста b) факторы свертывания и тромбоспондин (тромбоспондин усиливает адгезию и агрегацию тромбоцитов; тромбопластин, фактор V, GMP 140 белок семейства селектинов, рецептор адгезии) на внутренней поверхности мембраны имеются рецепторы для факторов свертывания дельта-гранулы содержат: АДФ, АТФ, ионы кальция, серотонин, гистамин. лямбда-гранулы или азурофильные гранулы, или лизосомы:
 На поверхности тромбоцита имеется большое количество фосфатных групп - компонентов мембранных фосфолипидов и фосфопротеинов. Эти группы придают тромбоцитам отрицательный заряд. Часть из них «закрыта» и экспрессируется после активации тромбоцита стимулирующими агентами – АДФ, адреналином, коллагеном, микрофибриллами и др. С их помощью происходит связывание ряда факторов свёртывания крови.
На поверхности тромбоцита имеется большое количество фосфатных групп - компонентов мембранных фосфолипидов и фосфопротеинов. Эти группы придают тромбоцитам отрицательный заряд. Часть из них «закрыта» и экспрессируется после активации тромбоцита стимулирующими агентами – АДФ, адреналином, коллагеном, микрофибриллами и др. С их помощью происходит связывание ряда факторов свёртывания крови.
 свойства: n При воздействии разнообразных соединений (тромбина, коллагена, ADP, эпинефрина и др. ) выявлены характерные последовательные изменения тромбоцитов, которые условно разделяют на несколько стадий. n 1) изменение формы — клетки дискоидной формы превращаются в сферические; n 2)внутренняя поверхность мембраны гранул, содержащая рецепторы для молекул адгезии и факторов свертывания, становится доступной для неактивных факторов свертывания крови, которые при взаимодействии с этими рецепторами, сначала фиксируются, а затем активируются;
свойства: n При воздействии разнообразных соединений (тромбина, коллагена, ADP, эпинефрина и др. ) выявлены характерные последовательные изменения тромбоцитов, которые условно разделяют на несколько стадий. n 1) изменение формы — клетки дискоидной формы превращаются в сферические; n 2)внутренняя поверхность мембраны гранул, содержащая рецепторы для молекул адгезии и факторов свертывания, становится доступной для неактивных факторов свертывания крови, которые при взаимодействии с этими рецепторами, сначала фиксируются, а затем активируются;
 3) слипание тромбоцитов друг с другом — агрегация; 4) синтез простагландинов и тромбоксанов; 5) секреция содержимого из плотных гранул; 6) секреция содержимого из а гранул. Последние две стадии называются реакцией высвобождения, которая завершается образованием и уплотнением сгустка.
3) слипание тромбоцитов друг с другом — агрегация; 4) синтез простагландинов и тромбоксанов; 5) секреция содержимого из плотных гранул; 6) секреция содержимого из а гранул. Последние две стадии называются реакцией высвобождения, которая завершается образованием и уплотнением сгустка.
 Функции n При нарушении целостности стенки кровеносных сосудов обеспечивают свертывание крови в поврежденном участке и предотвращают кровопотерю. n Принимают участие в защите организма от чужеродных агентов. Они обладают фагоцитарной активностью, содержат Ig. G, являются источником лизоцима и β лизинов, способных разрушать мембрану некоторых бактерий. Кроме того, в их составе обнаружены пептидные факторы, при травме сосудов защищающие организм от попадания болезнетворных микроорганизмов.
Функции n При нарушении целостности стенки кровеносных сосудов обеспечивают свертывание крови в поврежденном участке и предотвращают кровопотерю. n Принимают участие в защите организма от чужеродных агентов. Они обладают фагоцитарной активностью, содержат Ig. G, являются источником лизоцима и β лизинов, способных разрушать мембрану некоторых бактерий. Кроме того, в их составе обнаружены пептидные факторы, при травме сосудов защищающие организм от попадания болезнетворных микроорганизмов.
 Тромбоцитопоэз n Регуляторами тромбоцитопоэза являются тромбо цитопоэтины кратковременного и длительного действия. Они образуются в костном мозге, селезенке, печени, а также входят в состав мегакариоцитов и тромбоцитов. n Тромбоцитопоэтины кратковременного действия усиливают отшнуровку кровяных пластинок от мегакариоцитов и ускоряют их поступление в кровь. Тромбоцитопоэтины длительного действия способствуют переходу предшественников гигантских клеток костного мозга в зрелые мегакариоциты. На активность тромбоцитопоэтинов непосредственное влияние оказы вают ИЛ 6 и ИЛ 1.
Тромбоцитопоэз n Регуляторами тромбоцитопоэза являются тромбо цитопоэтины кратковременного и длительного действия. Они образуются в костном мозге, селезенке, печени, а также входят в состав мегакариоцитов и тромбоцитов. n Тромбоцитопоэтины кратковременного действия усиливают отшнуровку кровяных пластинок от мегакариоцитов и ускоряют их поступление в кровь. Тромбоцитопоэтины длительного действия способствуют переходу предшественников гигантских клеток костного мозга в зрелые мегакариоциты. На активность тромбоцитопоэтинов непосредственное влияние оказы вают ИЛ 6 и ИЛ 1.
 ГЕМОПОЭЗ n Ежедневно в организме взрослого человека весом 70 кг погибают более 0, 5 триллиона дифференцированных клеток, включая 200 млрд эритроцитов и 70 млрд нейтрофилов. n В норме скорость образования клеток крови равна скорости разрушения, но в ответ на увеличение потребности один или несколько клеточных ростков гиперплазируются. n Таким образом, поддержание постоянства состава крови требует непрерывного образования новых клеток. Этот процесс называется кроветворением. Он обеспечивается стволовыми кроветворными клетками небольшой (0, 01%) фракцией костномозговых клеток, из которых возникают все клетки крови.
ГЕМОПОЭЗ n Ежедневно в организме взрослого человека весом 70 кг погибают более 0, 5 триллиона дифференцированных клеток, включая 200 млрд эритроцитов и 70 млрд нейтрофилов. n В норме скорость образования клеток крови равна скорости разрушения, но в ответ на увеличение потребности один или несколько клеточных ростков гиперплазируются. n Таким образом, поддержание постоянства состава крови требует непрерывного образования новых клеток. Этот процесс называется кроветворением. Он обеспечивается стволовыми кроветворными клетками небольшой (0, 01%) фракцией костномозговых клеток, из которых возникают все клетки крови.
 Локализация кроветворения n Кроветворение у эмбриона n выделяют 3 этапа кроветворения: n мезобластический, n печёночный и n медуллярный.
Локализация кроветворения n Кроветворение у эмбриона n выделяют 3 этапа кроветворения: n мезобластический, n печёночный и n медуллярный.
 Локализация n 1. Впервые кроветворение начинается в стенке желточного мешка (1). n Здесь появляются скопления мезенхимных клеток кровяные островки. n 2. Периферические клетки островков уплощаются и образуют стенку первичных сосудов (2)
Локализация n 1. Впервые кроветворение начинается в стенке желточного мешка (1). n Здесь появляются скопления мезенхимных клеток кровяные островки. n 2. Периферические клетки островков уплощаются и образуют стенку первичных сосудов (2)
 n Внутрисосудистое образование первичных эритроцитов n 1. Центральные клетки (3) кровяных островков n округляются и внутри сосудов, т. е. интраваскулярно, вступают в т. н. мегалобластический эритропоэз: n 2. Образующиеся первичные эритроциты n имеют большой размер, n часто содержат ядра, n содержат особый вид гемоглобина т. н. Hb эмбриона.
n Внутрисосудистое образование первичных эритроцитов n 1. Центральные клетки (3) кровяных островков n округляются и внутри сосудов, т. е. интраваскулярно, вступают в т. н. мегалобластический эритропоэз: n 2. Образующиеся первичные эритроциты n имеют большой размер, n часто содержат ядра, n содержат особый вид гемоглобина т. н. Hb эмбриона.
 n Позднее в желточном мешке n начинается нормобластический эритропоэз образование обычных эритроцитов (нормоцитов); n вне сосудов (экстраваскулярно) образуются первичные лейкоциты (только гранулоциты); n часть стволовых клеток (1 ой генерации) выходит в кровь и переносится в зачаток печени.
n Позднее в желточном мешке n начинается нормобластический эритропоэз образование обычных эритроцитов (нормоцитов); n вне сосудов (экстраваскулярно) образуются первичные лейкоциты (только гранулоциты); n часть стволовых клеток (1 ой генерации) выходит в кровь и переносится в зачаток печени.
 Печеночный этап n С 6 й недели эмбрионального развития центром кроветворения становится печень. n а) процесс (в т. ч. эритропоэз) происходит экстраваскулярно вокруг капилляров, врастающих в печёночные дольки; n б) образуются все форменные элементы крови; n в) при этом эритроциты имеют обычный размер и n содержат фетальный гемоглобин (Hb F). n 3. Наряду с клетками крови, из печени разносятся также стволовые кроветворные клетки 2 ой генерации.
Печеночный этап n С 6 й недели эмбрионального развития центром кроветворения становится печень. n а) процесс (в т. ч. эритропоэз) происходит экстраваскулярно вокруг капилляров, врастающих в печёночные дольки; n б) образуются все форменные элементы крови; n в) при этом эритроциты имеют обычный размер и n содержат фетальный гемоглобин (Hb F). n 3. Наряду с клетками крови, из печени разносятся также стволовые кроветворные клетки 2 ой генерации.
 медуллярный этап n Кроветворные органы на медуллярном этапе. n 1. стволовые клетки (2 -й генерации) оседают в зачатках n n тимуса, лимфоузлов, селезёнки и красного костного мозга. n 2. Все эти органы включаются в кроветворение на медуллярном этапе; причём, n кроветворение в них происходит экстраваскулярно, n эритроциты (если они образуются в органе) содержат, в основном, Hb. F и в меньшей степени Hb. A (гемоглобин взрослых); n Эти органы остаются органами кроветворения также после рождения. n б) Но суживается спектр образуемых в них клеток.
медуллярный этап n Кроветворные органы на медуллярном этапе. n 1. стволовые клетки (2 -й генерации) оседают в зачатках n n тимуса, лимфоузлов, селезёнки и красного костного мозга. n 2. Все эти органы включаются в кроветворение на медуллярном этапе; причём, n кроветворение в них происходит экстраваскулярно, n эритроциты (если они образуются в органе) содержат, в основном, Hb. F и в меньшей степени Hb. A (гемоглобин взрослых); n Эти органы остаются органами кроветворения также после рождения. n б) Но суживается спектр образуемых в них клеток.
 Тимус. n 1. Красный костный мозг начинают покидать предшественники Т лимфоцитов. n Своё антигеннезависимое созревание они заканчивают в тимусе. n одновременно элиминируются те Т лимфоциты, которые настроены против собственных антигенных детерминант организма. n 2. Кроветворная роль тимуса быстро суживается до одной, функции обеспечения антигеннезависимого созревания Т лимфоцитов.
Тимус. n 1. Красный костный мозг начинают покидать предшественники Т лимфоцитов. n Своё антигеннезависимое созревание они заканчивают в тимусе. n одновременно элиминируются те Т лимфоциты, которые настроены против собственных антигенных детерминант организма. n 2. Кроветворная роль тимуса быстро суживается до одной, функции обеспечения антигеннезависимого созревания Т лимфоцитов.
 Лимфоузлы и селезёнка n n n 1. а) Вначале в лимфоузлах и селезёнке образуются все виды форменных элементов крови. б) Такая способность сохраняется в лимфоузлах до 15 -й недели развития, а в селезёнке - до рождения. n 2. а) Затем эти органы концентрируются лишь на одной функции антигензависимом созревании В- и Т-лимфоцитов. n Т. е здесь образуются лимфатические узелки; n в после их оседают В- и Т-лимфоциты из, соответственно, красного костного мозга и тимуса; n после антигенной стимуляции соответствующие клоны лимфоцитов вступают в активную пролиферацию и в дальнейшую дифференцировку.
Лимфоузлы и селезёнка n n n 1. а) Вначале в лимфоузлах и селезёнке образуются все виды форменных элементов крови. б) Такая способность сохраняется в лимфоузлах до 15 -й недели развития, а в селезёнке - до рождения. n 2. а) Затем эти органы концентрируются лишь на одной функции антигензависимом созревании В- и Т-лимфоцитов. n Т. е здесь образуются лимфатические узелки; n в после их оседают В- и Т-лимфоциты из, соответственно, красного костного мозга и тимуса; n после антигенной стимуляции соответствующие клоны лимфоцитов вступают в активную пролиферацию и в дальнейшую дифференцировку.
 Красный костный мозг n 1. Вначале в красном костном мозгу тоже образуются все клетки крови, n а затем его начинают покидать предшественники Т лимфоцитов. n 2. Таким образом, у взрослого красный костный мозг сохраняет способность образовывать n все виды клеток крови, кроме Т лимфоцитов, n а также предшественники Т лимфоцитов. n 3. Причём, на протяжении всего последующего онтогенеза в нём сохраняются стволовые кроветворные клетки 3 го поколения.
Красный костный мозг n 1. Вначале в красном костном мозгу тоже образуются все клетки крови, n а затем его начинают покидать предшественники Т лимфоцитов. n 2. Таким образом, у взрослого красный костный мозг сохраняет способность образовывать n все виды клеток крови, кроме Т лимфоцитов, n а также предшественники Т лимфоцитов. n 3. Причём, на протяжении всего последующего онтогенеза в нём сохраняются стволовые кроветворные клетки 3 го поколения.
 Красный костный мозг n 1. Локализация - губчатое вещество плоских и губчатых костей, а также эпифизов трубчатых костей. n У детей (до 12 -18 лет) - также диафизы трубчатых костей (затем красный костный мозг замещается на жёлтый костный мозг). n 2. Консистенция - полужидкая; n Общая масса - 3, 5 кг. n 3. Функция: в красном костном мозгу происходят все стадии созревания n n n эритроцитов, гранулоцитов, моноцитов, тромбоцитов и В-лимфоцитов (нестимулированых).
Красный костный мозг n 1. Локализация - губчатое вещество плоских и губчатых костей, а также эпифизов трубчатых костей. n У детей (до 12 -18 лет) - также диафизы трубчатых костей (затем красный костный мозг замещается на жёлтый костный мозг). n 2. Консистенция - полужидкая; n Общая масса - 3, 5 кг. n 3. Функция: в красном костном мозгу происходят все стадии созревания n n n эритроцитов, гранулоцитов, моноцитов, тромбоцитов и В-лимфоцитов (нестимулированых).
 ГЕМОПОЭЗ
ГЕМОПОЭЗ
 n Гематопоэтические клетки происходят от очень небольшого числа тотипотентных стволовых клеток, которые дифференцируются, давая все линии клеток крови. Тотипотентные стволовые клетки не специализированы. Более специализированы плюрипотентные стволовые клетки. Они способны дифференцироваться, давая только определенные линии клеток. Различают две популяции плюрипотентных клеток лимфоидные и миелоидные.
n Гематопоэтические клетки происходят от очень небольшого числа тотипотентных стволовых клеток, которые дифференцируются, давая все линии клеток крови. Тотипотентные стволовые клетки не специализированы. Более специализированы плюрипотентные стволовые клетки. Они способны дифференцироваться, давая только определенные линии клеток. Различают две популяции плюрипотентных клеток лимфоидные и миелоидные.
 n В схеме К. стволовая клетка и клетки второго и третьего рядов находятся в лимфоцитоподобном и бластном (бластом называется клетка, имеющая обычно неширокую цитоплазму, нежноструктурное ядро, отличающееся равномерностью калибра и окраски хроматиновых нитей) виде. n На уровне поэтинчувствительных клеток происходит дальнейшее ограничение дифференцировочных возможностей клеток. На этой и следующих морфологически распознаваемых стадиях дифференцировки подавляющее большинство клеток находится в состоянии пролиферации.
n В схеме К. стволовая клетка и клетки второго и третьего рядов находятся в лимфоцитоподобном и бластном (бластом называется клетка, имеющая обычно неширокую цитоплазму, нежноструктурное ядро, отличающееся равномерностью калибра и окраски хроматиновых нитей) виде. n На уровне поэтинчувствительных клеток происходит дальнейшее ограничение дифференцировочных возможностей клеток. На этой и следующих морфологически распознаваемых стадиях дифференцировки подавляющее большинство клеток находится в состоянии пролиферации.
 n В процессе дифференцировки морфологически распознаваемые клетки эритроцитарного ряда претерпевают 5— 6 митозов; гранулоцитарные клетки — 4 митоза; при моноцитопоэзе от монобласта до макрофага происходит 7— 8 митозов. В мегакариоцитопоэзе выделяют несколько морфологически различимых предшественников, которые начиная с мегакариобласта претерпевают 4— 5 эндомитозов (деления ядра без деления цитоплазмы).
n В процессе дифференцировки морфологически распознаваемые клетки эритроцитарного ряда претерпевают 5— 6 митозов; гранулоцитарные клетки — 4 митоза; при моноцитопоэзе от монобласта до макрофага происходит 7— 8 митозов. В мегакариоцитопоэзе выделяют несколько морфологически различимых предшественников, которые начиная с мегакариобласта претерпевают 4— 5 эндомитозов (деления ядра без деления цитоплазмы).
 Выделяют два вида кроветворения: а) миелопоэз образование всех форменных элементов крови, кроме лимфоцитов, т. е. n n эритроцитов, гранулоцитов, моноцитов и тромбоцитов; б) лимфопоэз образование лимфоцитов (Т и В клеток).
Выделяют два вида кроветворения: а) миелопоэз образование всех форменных элементов крови, кроме лимфоцитов, т. е. n n эритроцитов, гранулоцитов, моноцитов и тромбоцитов; б) лимфопоэз образование лимфоцитов (Т и В клеток).
 Ткань, в которой происходит миелопоэз, называется миелоидной. Ткань, в которой происходит дозревание и функционирование лимфоцитов, называется лимфоидной.
Ткань, в которой происходит миелопоэз, называется миелоидной. Ткань, в которой происходит дозревание и функционирование лимфоцитов, называется лимфоидной.

 Ростовые кроветворные факторы: n Ответ системы кроветворения на внешние стимулы регулируется n n соответствующими факторами роста. В ответ на бактериальную инфекцию вырабатываются и поступают в кровоток М КСФ , ГМ КСФ и Г КСФ . Многие клетки стромы выделяют также провоспалительные цитокины ИЛ 1, ИЛ Кроме прямого действия на клетки предшественники они запускают каскад реакций, ведущих к образованию других цитокинов. Существует около 16 цитокинов (11 интерлейкинов, макрофаговый CSF, эритропоэтин, гранулоцитарный (G) CFS, GM CSF и гамма интерферон). Активированные Т лимфоциты синтезируют еще одну группу цитокинов ( ИЛ 2 , ИЛ 3 , ИЛ 4 , ИЛ 5 и интерферон альфа ). Эритропоэз регулируется эритропоэтином. После рождения эритропоэтин синтезируется прежде всего в почках. При снижении оксигенации крови усиливается транскрипция гена эритропоэтина.
Ростовые кроветворные факторы: n Ответ системы кроветворения на внешние стимулы регулируется n n соответствующими факторами роста. В ответ на бактериальную инфекцию вырабатываются и поступают в кровоток М КСФ , ГМ КСФ и Г КСФ . Многие клетки стромы выделяют также провоспалительные цитокины ИЛ 1, ИЛ Кроме прямого действия на клетки предшественники они запускают каскад реакций, ведущих к образованию других цитокинов. Существует около 16 цитокинов (11 интерлейкинов, макрофаговый CSF, эритропоэтин, гранулоцитарный (G) CFS, GM CSF и гамма интерферон). Активированные Т лимфоциты синтезируют еще одну группу цитокинов ( ИЛ 2 , ИЛ 3 , ИЛ 4 , ИЛ 5 и интерферон альфа ). Эритропоэз регулируется эритропоэтином. После рождения эритропоэтин синтезируется прежде всего в почках. При снижении оксигенации крови усиливается транскрипция гена эритропоэтина.
 Эритропоэз n В эритроцитопоэзе самой молодой клеткой является эритробласт (ее называют также проэритробластом), который имеет бластную структуру и обычно круглое ядро. Цитоплазма при окраске темно синяя, располагается узким ободком, часто образует своеобразные выросты. В отношении клеток эритрокариоцитарного ряда нет единой номенклатуры. Их называют как нормобластами, так и эритробластами. Поскольку для других рядов термин «бласт» применяется лишь для клеток родоначальниц того или иного ростка (отсюда и название «бласт» — росток), все клетки, являющиеся потомством эритробласта, должны иметь в названии окончание «цит» . Поэтому термин «нормобласты» был заменен на «нормоциты» .
Эритропоэз n В эритроцитопоэзе самой молодой клеткой является эритробласт (ее называют также проэритробластом), который имеет бластную структуру и обычно круглое ядро. Цитоплазма при окраске темно синяя, располагается узким ободком, часто образует своеобразные выросты. В отношении клеток эритрокариоцитарного ряда нет единой номенклатуры. Их называют как нормобластами, так и эритробластами. Поскольку для других рядов термин «бласт» применяется лишь для клеток родоначальниц того или иного ростка (отсюда и название «бласт» — росток), все клетки, являющиеся потомством эритробласта, должны иметь в названии окончание «цит» . Поэтому термин «нормобласты» был заменен на «нормоциты» .
 n За эритробластом появляется пронормоцит, который отличается от эритробласта более грубым строением ядра, хотя оно и сохраняет правильную структуру хроматиновых нитей. Диаметр ядра меньше, чем у эритробласта, ободок цитоплазмы шире, видна перинуклеарная зона просветления. При изучении миелограммы пронормоцит легко спутать с эритробластом. В связи с трудностью разделения этих клеток некоторые авторы предлагают в практической гематологии их вообще не дифференцировать. Далее следует базофильный нормоцит, у которого грубоглыбчатое ядро имеет колосовидную структуру, а цитоплазма окрашена в темно синий цвет. Следующий — полихроматофильный нормоцит отличается еще более плотной структурой ядра; цитоплазма занимает бо льшую часть клетки и имеет базофильную (за счет структур, содержащих РНК) и оксифильную (в связи с появлением достаточного количества гемоглобина) окраску.
n За эритробластом появляется пронормоцит, который отличается от эритробласта более грубым строением ядра, хотя оно и сохраняет правильную структуру хроматиновых нитей. Диаметр ядра меньше, чем у эритробласта, ободок цитоплазмы шире, видна перинуклеарная зона просветления. При изучении миелограммы пронормоцит легко спутать с эритробластом. В связи с трудностью разделения этих клеток некоторые авторы предлагают в практической гематологии их вообще не дифференцировать. Далее следует базофильный нормоцит, у которого грубоглыбчатое ядро имеет колосовидную структуру, а цитоплазма окрашена в темно синий цвет. Следующий — полихроматофильный нормоцит отличается еще более плотной структурой ядра; цитоплазма занимает бо льшую часть клетки и имеет базофильную (за счет структур, содержащих РНК) и оксифильную (в связи с появлением достаточного количества гемоглобина) окраску.
 Эритропоэз n Ход развития эритроцитов из стволовой клетки крови описывается последовательностью: n СКК » КОЕ ГЭММ > БОЕ Э » КОЕ Э > проэритробласт > (базофильный эритробласт > полихроматофильный эритробласт > оксифильный (ортохроматофильный) эритробласт —> ретикулоцит » эритроцит. n Эритрон эритроидньгй дифферон, представляющий собой совокупность указанных форм от эритроидных родоначальных клеток до зрелых эритроцитов (включая циркулирующие в крови). n БОЕ Э и КОЕ Э. БОЕ Э бурст образующая единица (от англ. burst взрыв) названа так по своей способности быстро (взрывоподобно) образовывать на полутвердой среде колонию эритроидных клеток численностью в несколько сотен элементов. Она отличается от развивающейся из нее КОЕ Э более высокой пролиферативной активностью, высокой чувствительностью к ИЛ 3 и низкой к эритропоэтину.
Эритропоэз n Ход развития эритроцитов из стволовой клетки крови описывается последовательностью: n СКК » КОЕ ГЭММ > БОЕ Э » КОЕ Э > проэритробласт > (базофильный эритробласт > полихроматофильный эритробласт > оксифильный (ортохроматофильный) эритробласт —> ретикулоцит » эритроцит. n Эритрон эритроидньгй дифферон, представляющий собой совокупность указанных форм от эритроидных родоначальных клеток до зрелых эритроцитов (включая циркулирующие в крови). n БОЕ Э и КОЕ Э. БОЕ Э бурст образующая единица (от англ. burst взрыв) названа так по своей способности быстро (взрывоподобно) образовывать на полутвердой среде колонию эритроидных клеток численностью в несколько сотен элементов. Она отличается от развивающейся из нее КОЕ Э более высокой пролиферативной активностью, высокой чувствительностью к ИЛ 3 и низкой к эритропоэтину.
 n Процесс дифференцировки предшественников эритроцита» в зрелые форменные элементы включает: n (1) уменьшение размеров клетки; n (2) выработку и накопление гемоглобина в цитоплазме; n (3) постепенное снижение содержания и в конечном итоге утрата всех органелл; n (4) изменение окраски цитоплазмы от интенсивно базофильной (в связи с большим числом полирибосом) до оксифильной (обусловленной присутствием гемоглобина); n (5) снижение, а в дальнейшем (в конце стадии оксифильного эритробласта) утрату способности к делению; n (6) конденсацию ядра и его последующее удаление из клетки. Проэритробласт крупная клетка (диаметром около 18 22 мкм) с большим сферическим ядром, содержащим мелкодисперсный хроматин и два три бледных ядрышка. Цитоплазма умеренно базофильна вследствие присутствия свободных рибосом. Клетка интенсивно проли ферирует, давая начало эритробластам. Последние развиваются в составе так называемых эритробластических островков.
n Процесс дифференцировки предшественников эритроцита» в зрелые форменные элементы включает: n (1) уменьшение размеров клетки; n (2) выработку и накопление гемоглобина в цитоплазме; n (3) постепенное снижение содержания и в конечном итоге утрата всех органелл; n (4) изменение окраски цитоплазмы от интенсивно базофильной (в связи с большим числом полирибосом) до оксифильной (обусловленной присутствием гемоглобина); n (5) снижение, а в дальнейшем (в конце стадии оксифильного эритробласта) утрату способности к делению; n (6) конденсацию ядра и его последующее удаление из клетки. Проэритробласт крупная клетка (диаметром около 18 22 мкм) с большим сферическим ядром, содержащим мелкодисперсный хроматин и два три бледных ядрышка. Цитоплазма умеренно базофильна вследствие присутствия свободных рибосом. Клетка интенсивно проли ферирует, давая начало эритробластам. Последние развиваются в составе так называемых эритробластических островков.
 ЛИМФА
ЛИМФА
 n Лимфа полупрозрачная желтоватая жидкость образуется из тканевой жидкости, попавшей в лимфатические капилляры.
n Лимфа полупрозрачная желтоватая жидкость образуется из тканевой жидкости, попавшей в лимфатические капилляры.
 n Объем циркулирующей лимфы у человека в среднем 1, 5 2 л. Лимфа состоит из лимфоплазмы и форменных элементов, в периферической лимфе клеток очень мало, в центральной лимфе существенно больше. Актуальная реакция щелочная, р. Н находится в диапазоне 8, 4 9, 2. Осмотическое давление лимфы близко плазме крови, а онкотическое существенно ниже из за меньшой концентрации в ней белков. Соответственно, меньше и вязкость лимфы. n Cодержит фибриноген и протромбин
n Объем циркулирующей лимфы у человека в среднем 1, 5 2 л. Лимфа состоит из лимфоплазмы и форменных элементов, в периферической лимфе клеток очень мало, в центральной лимфе существенно больше. Актуальная реакция щелочная, р. Н находится в диапазоне 8, 4 9, 2. Осмотическое давление лимфы близко плазме крови, а онкотическое существенно ниже из за меньшой концентрации в ней белков. Соответственно, меньше и вязкость лимфы. n Cодержит фибриноген и протромбин
 n Выделяют так называемую периферическую лимфу, не прошедшую через лимфатические узлы; центральную, содержащуюся в грудном протоке; промежуточную (транзиторную), прошедшую через 1— 2 лимфатических узла. Их клеточный и химический составы неодинаковы. Центральная лимфа содержит больше белка и клеточных элементов, состав периферической Л. меняется в зависимости от особенностей деятельности и обмена веществ органа (части тела), откуда она оттекает. Так, лимфа, оттекающая от кишечника, содержит значительное количество ферментов гормонов), жиров и жирорастворимых веществ, витаминов; Лимфа, оттекающая от желез внутренней секреции, характеризуется более высоким содержанием гормонов, продуцируемых этими железами, и т. д.
n Выделяют так называемую периферическую лимфу, не прошедшую через лимфатические узлы; центральную, содержащуюся в грудном протоке; промежуточную (транзиторную), прошедшую через 1— 2 лимфатических узла. Их клеточный и химический составы неодинаковы. Центральная лимфа содержит больше белка и клеточных элементов, состав периферической Л. меняется в зависимости от особенностей деятельности и обмена веществ органа (части тела), откуда она оттекает. Так, лимфа, оттекающая от кишечника, содержит значительное количество ферментов гормонов), жиров и жирорастворимых веществ, витаминов; Лимфа, оттекающая от желез внутренней секреции, характеризуется более высоким содержанием гормонов, продуцируемых этими железами, и т. д.
 n Клеточный состав лимфы представлен в основном лимфоцитами. В лимфе грудного протока их число достигает 8*109/л. Эритроциты в лимфе в норме встречаются в ограниченном количестве, их число значительно возрастает при травмах тканей, тромбоциты в норме не определяются. Макрофаги и моноциты встречаются редко. Гранулоциты могут проникать в лимфу из очагов инфекции.
n Клеточный состав лимфы представлен в основном лимфоцитами. В лимфе грудного протока их число достигает 8*109/л. Эритроциты в лимфе в норме встречаются в ограниченном количестве, их число значительно возрастает при травмах тканей, тромбоциты в норме не определяются. Макрофаги и моноциты встречаются редко. Гранулоциты могут проникать в лимфу из очагов инфекции.
 Функции лимфы n поддержание постоянства состава и интерстициальной жидкости и микросреды клеток; объема n Наиболее важной функцией лимфатической системы является возврат белков, электролитов и воды из интерстициального пространства в кровь. За сутки в составе лимфы в кровоток возвращается более 100 г белка, профильтровавшегося из кровеносных капилляров в интерстициальное пространство. Нормальная лимфоциркуляция необходима для формирования максимально концентрированной мочи в почке. Через лимфатическую систему переносятся многие продукты, всасывающиеся в желудочно кишечном тракте, и прежде всего жиры. Некоторые крупномолекулярные ферменты, такие как гистаминаза и липаза, поступают в кровь исключительно по системе лимфатических сосудов.
Функции лимфы n поддержание постоянства состава и интерстициальной жидкости и микросреды клеток; объема n Наиболее важной функцией лимфатической системы является возврат белков, электролитов и воды из интерстициального пространства в кровь. За сутки в составе лимфы в кровоток возвращается более 100 г белка, профильтровавшегося из кровеносных капилляров в интерстициальное пространство. Нормальная лимфоциркуляция необходима для формирования максимально концентрированной мочи в почке. Через лимфатическую систему переносятся многие продукты, всасывающиеся в желудочно кишечном тракте, и прежде всего жиры. Некоторые крупномолекулярные ферменты, такие как гистаминаза и липаза, поступают в кровь исключительно по системе лимфатических сосудов.
 n Защита от чужеродных веществ и микроорганизмов В лимфатических узлах задерживаются и обезвреживаются некоторые вредные для организма вещества (чужеродные элементы, микроорганизмы). Таким образом, лимфатические узлы являются своеобразными биологическими фильтрами. n Лимфатическая система действует как транспортная система по удалению эритроцитов, оставшихся в ткани после кровотечения, а также по удалению и обезвреживанию бактерий, попавших в ткани. n Лимфатическая система продуцирует и осуществляет перенос лимфоцитов и других важнейших факторов иммунитета.
n Защита от чужеродных веществ и микроорганизмов В лимфатических узлах задерживаются и обезвреживаются некоторые вредные для организма вещества (чужеродные элементы, микроорганизмы). Таким образом, лимфатические узлы являются своеобразными биологическими фильтрами. n Лимфатическая система действует как транспортная система по удалению эритроцитов, оставшихся в ткани после кровотечения, а также по удалению и обезвреживанию бактерий, попавших в ткани. n Лимфатическая система продуцирует и осуществляет перенос лимфоцитов и других важнейших факторов иммунитета.
 n Обеспечение созревания клеток иммунитета В лимфатических узлах созревают и затем попадают в кровь специфические клетки иммунитета В-лимфоциты. n
n Обеспечение созревания клеток иммунитета В лимфатических узлах созревают и затем попадают в кровь специфические клетки иммунитета В-лимфоциты. n


